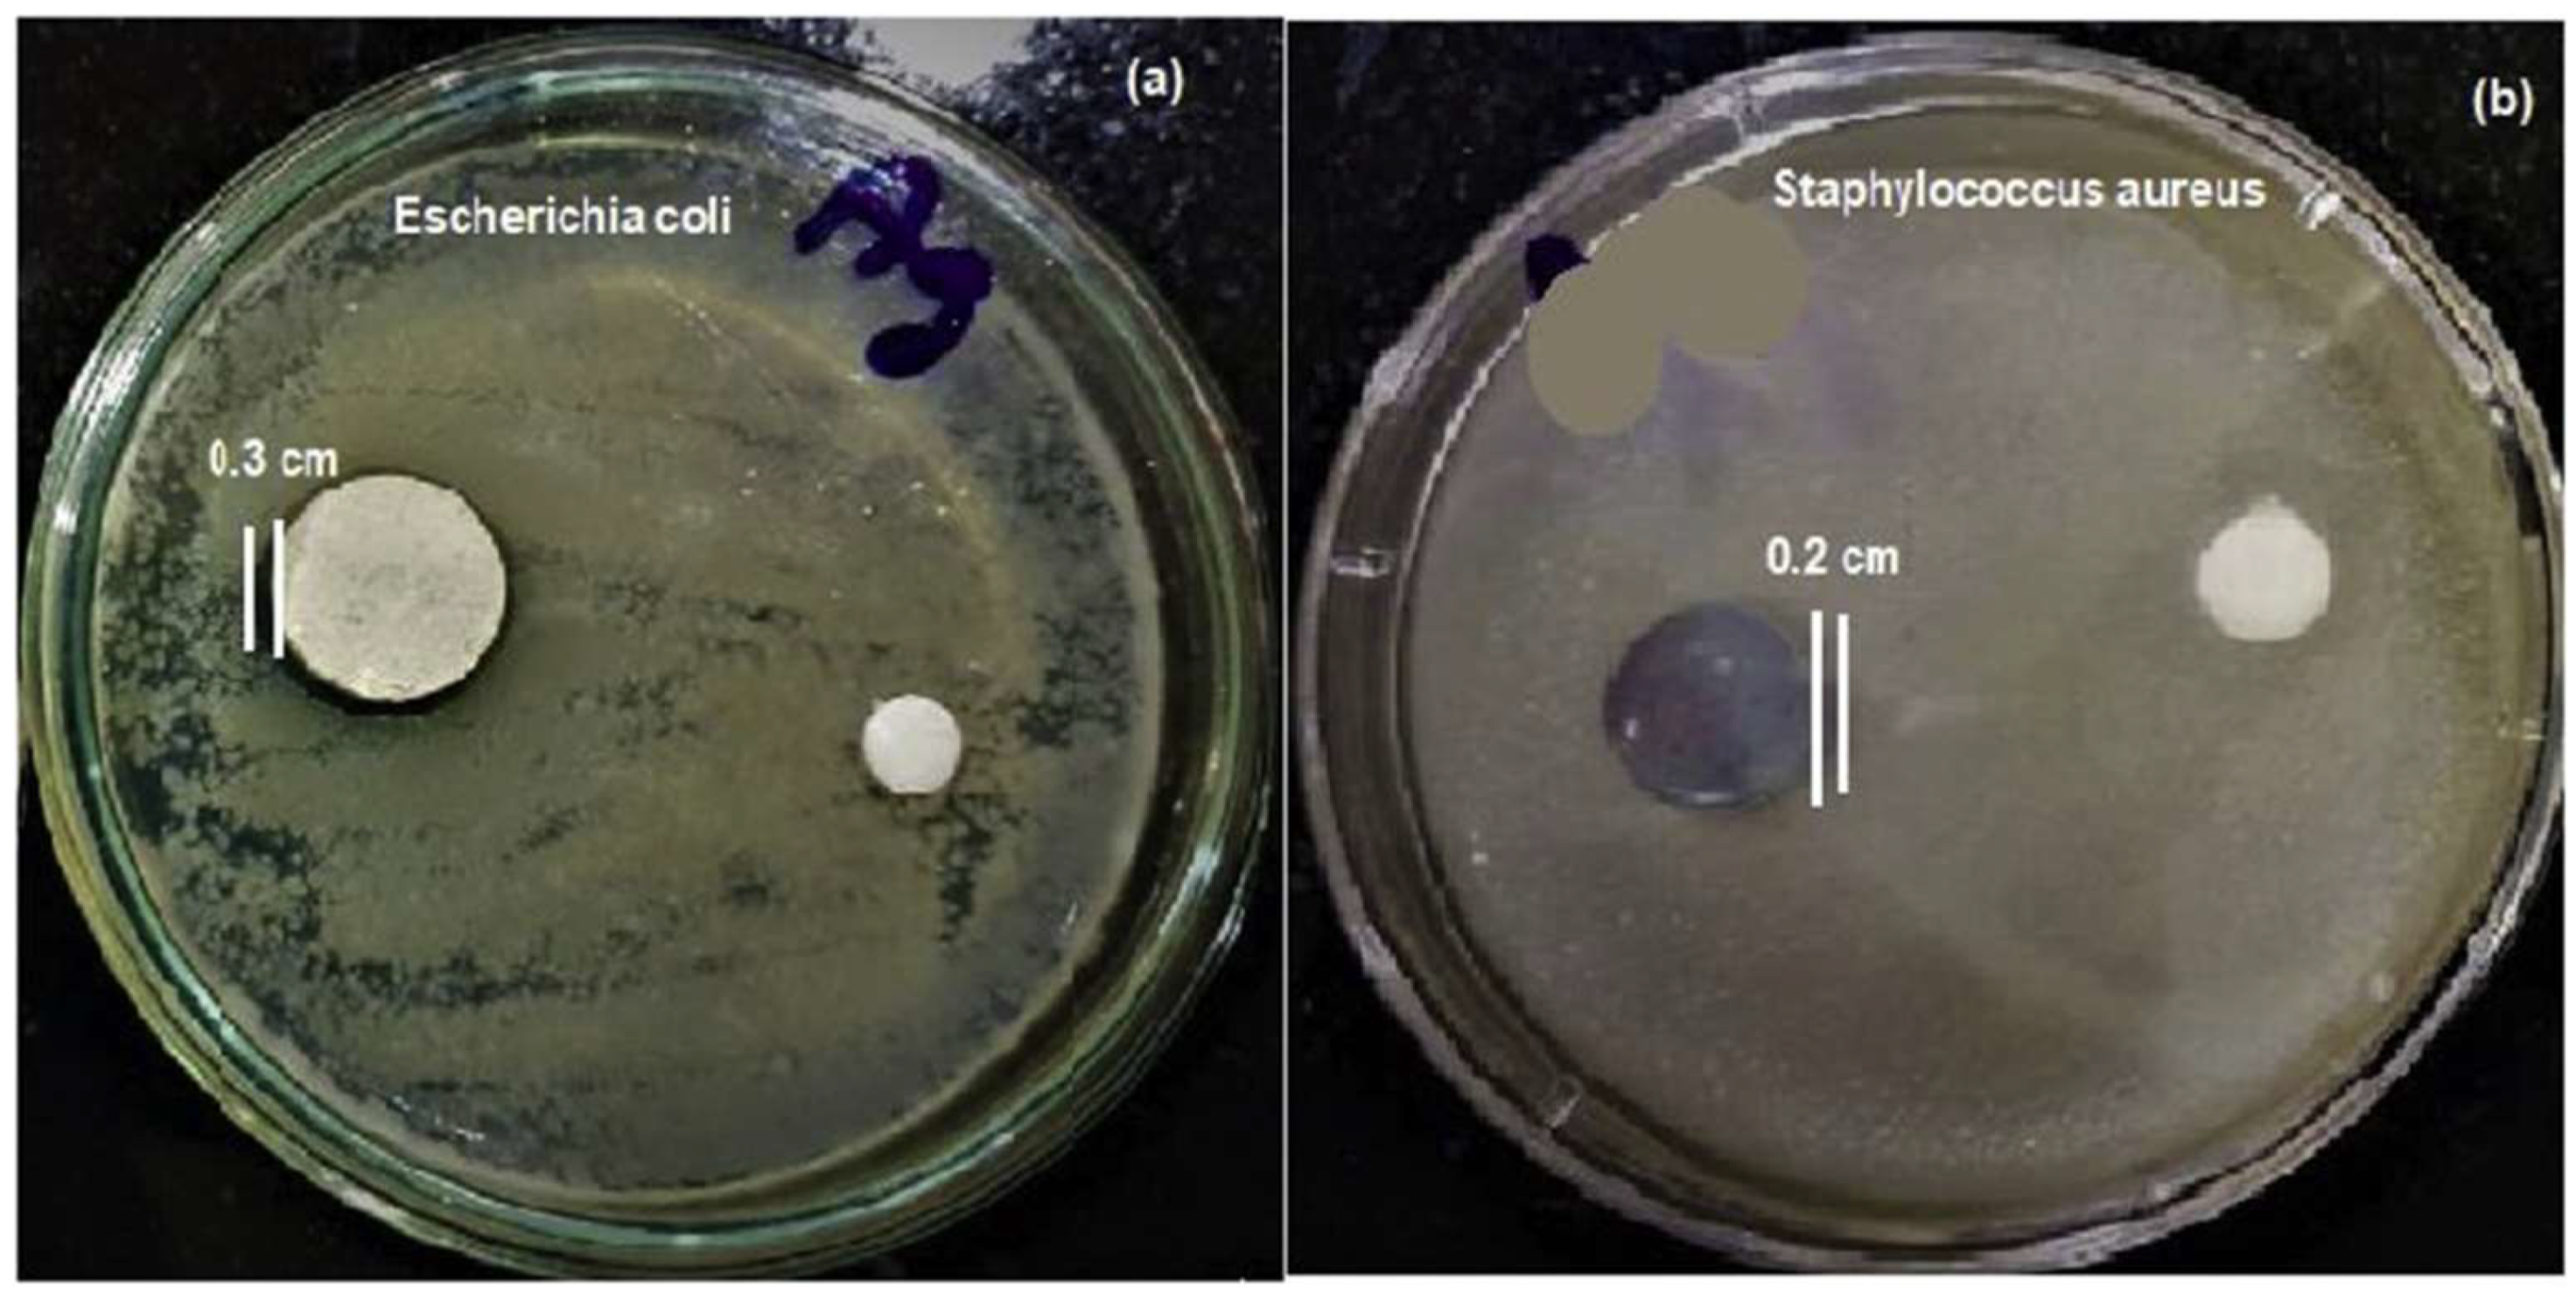
Gels 08 00323 g005 Gels 08 00323 g005

Recent Advancements in Materials and Coatings for Biomedical Implants
Abstract
1. Introduction
2. Biomaterials for Biomedical Applications
2.1. Ceramics
2.2. Polymers
Polymeric Gels
2.3. Metals and Alloys
2.3.1. Stainless Steels (SS)
2.3.2. Co-Cr Alloys
2.3.3. Ti Alloys
2.3.4. Mg Alloys
3. Need for Surface Modification of Bioimplants

3.1. Polyether Ether Ketone (PEEK)
3.2. Titanium Dioxide (TiO2)
| S. No. | Coatings | Deposition Method | Significance | Ref. |
|---|---|---|---|---|
| 1 | TiO2 coating on Ti substrates | Anodic oxidation | Potential rehabilitation to internal bone fracture | [167] |
| 2 | TiO2 coating on PEEK substrate | Dip coating | Recommended for maxillofacial and oral implants applications | [168] |
| 3 | TiO2/MoSe2/chitosan coating on Ti implants | Micro-arc oxidation process | Excellent in vivo and in vitro antibacterial property against S. mutans Better biocompatibility and hydrophilicity Better antibacterial properties | [169] |
| 4 | Poly(epsilon-caprolactone)/titania (PCL/TiO2) coating on Ti implants | Electrospinning technique | Good bioactivity against osteoblast cell Superior antibacterial against S. aureus Promoting cell attachment | [170] |
| 5 | TiO2 coating on Ti substrates | Direct lithographic anodic oxidation | Corrosion resistant | [171] |
| 6 | TiO2 nano coating | Anodizing oxidation technique | Better cell proliferation and adhesion Better osseointegration | [172] |
| 7 | Graphene/TiO2 coating on Ti substrate | Drop casting method | Better cell adhesion and proliferation behavior | [173] |
| 8 | TiO2/HAp bilayer coating on Ti substrate | MOCVD/Plasma spraying | Better hardness In vitro bioactivity | [174] |
| 9 | Y-doped TiO2 coating on Ti alloy | Plasma electrolytic oxidation method | Better antibacterial activity against E. coli and S. aureus | [175] |
| 10 | Fe3O4/TiO2 composite coating on Ti implants | Micro-arc oxidation process | Prevent inflammatory Better fibroblast response | [176] |
3.3. Transition Metal Nitrides
3.4. Carbon Based Coatings
3.5. Calcium Phosphates
3.6. Zirconia
3.7. Bioactive Glass Coatings
4. Summary and Future Directions
Author Contributions
Funding
Institutional Review Board Statement
Informed Consent Statement
Data Availability Statement
Conflicts of Interest
References
- Tang, G.; Liu, Z.; Liu, Y.; Yu, J.; Wang, X.; Tan, Z.; Ye, X. Recent Trends in the Development of Bone Regenerative Biomaterials. Front. Cell Dev. Biol. 2021, 9, 1001. [Google Scholar] [CrossRef] [PubMed]
- Campbell, A.A. Bioceramics for Implant Coatings. Mater. Today 2003, 6, 26–30. [Google Scholar] [CrossRef]
- Goharian, A. Fundamentals in Loosening and Osseointegration of Orthopedic Implants. Osseointegration Orthop. Implant. 2019, 1, 1–26. [Google Scholar] [CrossRef]
- Rodriguez-Gabella, T.; Voisine, P.; Puri, R.; Pibarot, P.; Rodés-Cabau, J. Aortic Bioprosthetic Valve Durability: Incidence, Mechanisms, Predictors, and Management of Surgical and Transcatheter Valve Degeneration. J. Am. Coll. Cardiol. 2017, 70, 1013–1028. [Google Scholar] [CrossRef] [PubMed]
- Prasad, K.; Bazaka, O.; Chua, M.; Rochford, M.; Fedrick, L.; Spoor, J.; Symes, R.; Tieppo, M.; Collins, C.; Cao, A.; et al. Metallic Biomaterials: Current Challenges and Opportunities. Materials 2017, 10, 884. [Google Scholar] [CrossRef]
- Shayesteh Moghaddam, N.; Taheri Andani, M.; Amerinatanzi, A.; Haberland, C.; Huff, S.; Miller, M.; Elahinia, M.; Dean, D. Metals for Bone Implants: Safety, Design, and Efficacy. Biomanufacturing Rev. 2016, 1, 1. [Google Scholar] [CrossRef]
- Bazaka, O.; Bazaka, K.; Kingshott, P.; Crawford, R.J.; Ivanova, E.P. Chapter 1 Metallic Implants for Biomedical Applications. In Chemistry of Inorganic Biomaterials; Royal Society of Chemistry: London, UK, 2021; Volume 8, pp. 1–98. [Google Scholar] [CrossRef]
- Liu, W.; Liu, S.; Wang, L. Surface Modification of Biomedical Titanium Alloy: Micromorphology, Microstructure Evolution and Biomedical Applications. Coatings 2019, 9, 249. [Google Scholar] [CrossRef]
- Nedela, O.; Slepicka, P.; Švorcík, V. Surface Modification of Polymer Substrates for Biomedical Applications. Materials 2017, 10, 1115. [Google Scholar] [CrossRef]
- Aherwar, A.; Singh, A.K.; Patnaik, A.; Aherwar, A.; Singh, A.K.; Patnaik, A. Current and Future Biocompatibility Aspects of Biomaterials for Hip Prosthesis. AIMS Bioeng. 2015, 3, 23–43. [Google Scholar] [CrossRef]
- Wang, G.; Zreiqat, H. Functional Coatings or Films for Hard-Tissue Applications. Materials 2010, 3, 3994. [Google Scholar] [CrossRef]
- Bhat, S.; Kumar, A. Biomaterials and Bioengineering Tomorrow’s Healthcare. Biomatter 2013, 3, e24717. [Google Scholar] [CrossRef] [PubMed]
- Joyce, K.; Fabra, G.T.; Bozkurt, Y.; Pandit, A. Bioactive Potential of Natural Biomaterials: Identification, Retention and Assessment of Biological Properties. Signal Transduct. Target. Ther. 2021, 6, 122. [Google Scholar] [CrossRef]
- Chandel, A.K.S.; Shimizu, A.; Hasegawa, K.; Ito, T. Advancement of Biomaterial-Based Postoperative Adhesion Barriers. Macromol. Biosci. 2021, 21, e2000395. [Google Scholar] [CrossRef] [PubMed]
- Kazimierczak, P.; Przekora, A. Osteoconductive and Osteoinductive Surface Modifications of Biomaterials for Bone Regeneration: A Concise Review. Coatings 2020, 10, 971. [Google Scholar] [CrossRef]
- Akhtar, M.; Uzair, S.A.; Rizwan, M.; Ur Rehman, M.A. The Improvement in Surface Properties of Metallic Implant via Magnetron Sputtering: Recent Progress and Remaining Challenges. Front. Mater. 2022, 8, 602. [Google Scholar] [CrossRef]
- Ahirwar, H.; Zhou, Y.; Mahapatra, C.; Ramakrishna, S.; Kumar, P.; Nanda, H.S. Materials for Orthopedic Bioimplants: Modulating Degradation and Surface Modification Using Integrated Nanomaterials. Coatings 2020, 10, 264. [Google Scholar] [CrossRef]
- Vladescu, A.; Surmeneva, M.A.; Cotrut, C.M.; Surmenev, R.A.; Antoniac, I.V. Bioceramic Coatings for Metallic Implants. Handb. Bioceram. Biocomposites 2016, 703–733. [Google Scholar] [CrossRef]
- Sarian, M.N.; Iqbal, N.; Sotoudehbagha, P.; Razavi, M.; Ahmed, Q.U.; Sukotjo, C.; Hermawan, H. Potential Bioactive Coating System for High-Performance Absorbable Magnesium Bone Implants. Bioact. Mater. 2022, 12, 42–63. [Google Scholar] [CrossRef]
- Pana, I.; Vladescu, A.; Constantin, L.R.; Sandu, I.G.; Dinu, M.; Cotrut, C.M. In Vitro Corrosion and Tribocorrosion Performance of Biocompatible Carbide Coatings. Coatings 2020, 10, 654. [Google Scholar] [CrossRef]
- Probst, J.; Gbureck, U.; Thull, R. Binary Nitride and Oxynitride PVD Coatings on Titanium for Biomedical Applications. Surf. Coat. Technol. 2001, 148, 226–233. [Google Scholar] [CrossRef]
- Dos Santos, G.A. The Importance of Metallic Materials as Biomaterials. Adv. Tissue Eng. Regen. Med. Open Access 2017, 3, 300–302. [Google Scholar] [CrossRef]
- Raghavendra, G.M.; Varaprasad, K.; Jayaramudu, T. Biomaterials: Design, Development and Biomedical Applications. Nanotechnol. Appl. Tissue Eng. 2015, 21–44. [Google Scholar] [CrossRef]
- Eliaz, N. Corrosion of Metallic Biomaterials: A Review. Materials 2019, 12, 407. [Google Scholar] [CrossRef] [PubMed]
- Prasadh, S.; Wong, R.C.W. Unraveling the Mechanical Strength of Biomaterials Used as a Bone Scaffold in Oral and Maxillofacial Defects. Oral Sci. Int. 2018, 15, 48–55. [Google Scholar] [CrossRef]
- Yamamuro, T. Bioceramics. Biomech. Biomater. Orthop. 2004, 22–33. [Google Scholar] [CrossRef]
- Shen, J.Z.; Fäldt, J. Requirements of Bioactive Ceramics for Dental Implants and Scaffolds. Adv. Ceram. Dent. 2014, 279–300. [Google Scholar] [CrossRef]
- Piconi, C.; Porporati, A.A. Bioinert Ceramics: Zirconia and Alumina. Handb. Bioceram. Biocomposites 2016, 59–89. [Google Scholar] [CrossRef]
- Barnes, D.H.; Moavenian, A.; Sharma, A.; Best, S.M. Biocompatibility of Ceramics. Mater. Med. Devices 2012, 128–134. [Google Scholar] [CrossRef]
- Elbadawi, M.; Meredith, J.; Hopkins, L. Ian Reaney Progress in Bioactive Metal and, Ceramic Implants for Load-Bearing Application. In Advanced Techniques in Bone Regeneration; InTech: Rijeka, Croatia, 2016. [Google Scholar] [CrossRef][Green Version]
- Whitehouse, M.R.; Blom, A.W. The Use of Ceramics as Bone Substitutes in Revision Hip Arthroplasty. Materials 2009, 2, 1895. [Google Scholar] [CrossRef]
- Huang, C.H.; Yoshimura, M. Direct Ceramic Coating of Calcium Phosphate Doped with Strontium via Reactive Growing Integration Layer Method on α-Ti Alloy. Sci. Rep. 2020, 10, 10602. [Google Scholar] [CrossRef]
- Lu, J.; Yu, H.; Chen, C. Biological Properties of Calcium Phosphate Biomaterials for Bone Repair: A Review. RSC Adv. 2018, 8, 2015–2033. [Google Scholar] [CrossRef] [PubMed]
- Fiume, E.; Magnaterra, G.; Rahdar, A.; Verné, E.; Baino, F. Hydroxyapatite for Biomedical Applications: A Short Overview. Ceramics 2021, 4, 542–563. [Google Scholar] [CrossRef]
- Díaz-Cuenca, A.; Rabadjieva, D.; Sezanova, K.; Gergulova, R.; Ilieva, R.; Tepavitcharova, S. Biocompatible Calcium Phosphate-Based Ceramics and Composites. Mater. Today Proc. 2022. [Google Scholar] [CrossRef]
- Kim, M.; An, S.; Huh, C.; Kim, C. Development of Zirconium-Based Alloys with Low Elastic Modulus for Dental Implant Materials. Appl. Sci. 2019, 9, 5281. [Google Scholar] [CrossRef]
- Ridzwan, M.I.Z.; Shuib, S.; Hassan, A.Y.; Shokri, A.A.; Mohammad Ibrahim, M.N. Problem of Stress Shielding and Improvement to the Hip Implant Designs: A Review. J. Med. Sci. 2007, 7, 460–467. [Google Scholar] [CrossRef]
- Fiorillo, L.; Cicciù, M.; Tozum, T.F.; Saccucci, M.; Orlando, C.; Romano, G.L.; D’amico, C.; Cervino, G. Endosseous Dental Implant Materials and Clinical Outcomes of Different Alloys: A Systematic Review. Materials 2022, 15, 1979. [Google Scholar] [CrossRef]
- Abbas, Z.; Dapporto, M.; Tampieri, A.; Sprio, S. Toughening of Bioceramic Composites for Bone Regeneration. J. Compos. Sci. 2021, 5, 259. [Google Scholar] [CrossRef]
- Díez-Pascual, M.; Li, M.; Komasa, S.; Hontsu, S.; Hashimoto, Y.; Okazaki, J. Structural Characterization and Osseointegrative Properties of Pulsed Laser-Deposited Fluorinated Hydroxyapatite Films on Nano-Zirconia for Implant Applications. Int. J. Mol. Sci. 2022, 23, 2416. [Google Scholar] [CrossRef]
- Smargiassi, A.; Bertacchini, J.; Checchi, M.; Cavani, F.; Ferretti, M.; Palumbo, C. Biocompatibility Analyses of Al2O3-Treated Titanium Plates Tested with Osteocyte and Fibroblast Cell Lines. Biomedicines 2017, 5, 32. [Google Scholar] [CrossRef]
- Lam, M.T.; Wu, J.C. Biomaterial Applications in Cardiovascular Tissue Repair and Regeneration. Expert Rev. Cardiovasc. Ther. 2012, 10, 1039. [Google Scholar] [CrossRef]
- Ohta, S.; Mitsuhashi, K.; Chandel, A.K.S.; Qi, P.; Nakamura, N.; Nakamichi, A.; Yoshida, H.; Yamaguchi, G.; Hara, Y.; Sasaki, R.; et al. Silver-Loaded Carboxymethyl Cellulose Nonwoven Sheet with Controlled Counterions for Infected Wound Healing. Carbohydr. Polym. 2022, 286, 119289. [Google Scholar] [CrossRef] [PubMed]
- Jiménez-Gómez, C.P.; Cecilia, J.A. Chitosan: A Natural Biopolymer with a Wide and Varied Range of Applications. Molecules 2020, 25, 3981. [Google Scholar] [CrossRef] [PubMed]
- Kołodziejska, M.; Jankowska, K.; Klak, M.; Wszoła, M. Chitosan as an Underrated Polymer in Modern Tissue Engineering. Nanomaterials 2021, 11, 19. [Google Scholar] [CrossRef]
- Cevik, P.; Schimmel, M.; Yilmaz, B. New Generation CAD-CAM Materials for Implant-Supported Definitive Frameworks Fabricated by Using Subtractive Technologies. BioMed Res. Int. 2022, 2022. [Google Scholar] [CrossRef] [PubMed]
- Vigier, S.; Fülöp, T. Exploring the Extracellular Matrix to Create Biomaterials. In Composition and Function of the Extracellular Matrix in the Human Body; InTech: Rijeka, Croatia, 2016. [Google Scholar] [CrossRef]
- Liao, C.; Li, Y.; Tjong, S.C. Polyetheretherketone and Its Composites for Bone Replacement and Regeneration. Polymers 2020, 12, 2858. [Google Scholar] [CrossRef] [PubMed]
- Koons, G.L.; Diba, M.; Mikos, A.G. Materials Design for Bone-Tissue Engineering. Nat. Rev. Mater. 2020, 5, 584–603. [Google Scholar] [CrossRef]
- Chandel, A.K.S.; Nutan, B.; Raval, I.H.; Jewrajka, S.K. Self-Assembly of Partially Alkylated Dextran-Graft-Poly[(2-Dimethylamino)Ethyl Methacrylate] Copolymer Facilitating Hydrophobic/Hydrophilic Drug Delivery and Improving Conetwork Hydrogel Properties. Biomacromolecules 2018, 19, 1142–1153. [Google Scholar] [CrossRef]
- Nutan, B.; Chandel, A.K.S.; Jewrajka, S.K. Liquid Prepolymer-Based in Situ Formation of Degradable Poly(Ethylene Glycol)-Linked-Poly(Caprolactone)-Linked-Poly(2-Dimethylaminoethyl)Methacrylate Amphiphilic Conetwork Gels Showing Polarity Driven Gelation and Bioadhesion. ACS Appl. Bio Mater. 2018, 1, 1606–1619. [Google Scholar] [CrossRef]
- Tallet, L.; Gribova, V.; Ploux, L.; Vrana, N.E.; Lavalle, P. New Smart Antimicrobial Hydrogels, Nanomaterials, and Coatings: Earlier Action, More Specific, Better Dosing? Adv. Healthc. Mater. 2021, 10, 2001199. [Google Scholar] [CrossRef]
- Paroha, S.; Chandel, A.K.S.; Dubey, R.D. Nanosystems for Drug Delivery of Coenzyme Q10. Environ. Chem. Lett. 2018, 16, 71–77. [Google Scholar] [CrossRef]
- Paroha, S.; Chandel, A.K.S.; Dubey, R.D. Nanotechnology Delivery Systems of Coenzyme Q10: Pharmacokinetic and Clinical Implications; Springer: Cham, Switzerland, 2017; pp. 213–228. [Google Scholar]
- Chandel, A.K.S.; Kumar, C.U.; Jewrajka, S.K. Effect of Polyethylene Glycol on Properties and Drug Encapsulation-Release Performance of Biodegradable/Cytocompatible Agarose-Polyethylene Glycol-Polycaprolactone Amphiphilic Co-Network Gels. ACS Appl. Mater. Interfaces 2016, 8, 3182–3192. [Google Scholar] [CrossRef] [PubMed]
- Dupin, D.; Deng, Z.; Guo, Y.; Zhao, X.; Du, T.; Zhu, J.; Xie, Y.; Wu, F.; Wang, Y.; Guan, M. Poly(N-Isopropylacrylamide) Based Electrically Conductive Hydrogels and Their Applications. Gels 2022, 8, 280. [Google Scholar] [CrossRef]
- Romischke, J.; Scherkus, A.; Saemann, M.; Krueger, S.; Bader, R.; Kragl, U.; Meyer, J. Swelling and Mechanical Characterization of Polyelectrolyte Hydrogels as Potential Synthetic Cartilage Substitute Materials. Gels 2022, 8, 296. [Google Scholar] [CrossRef]
- Liu, S.; Khan, R.; Zaman, M.; Salawi, A.; Khan, M.A.; Iqbal, M.O.; Riaz, R.; Ahmed, M.M.; Butt, M.H.; Alvi, M.N.; et al. Synthesis of Chemically Cross-Linked PH-Sensitive Hydrogels for the Sustained Delivery of Ezetimibe. Gels 2022, 8, 281. [Google Scholar] [CrossRef]
- Zhao, Y.; Song, S.; Ren, X.; Zhang, J.; Lin, Q.; Zhao, Y. Supramolecular Adhesive Hydrogels for Tissue Engineering Applications. Chem. Rev. 2022, 122, 5604–5640. [Google Scholar] [CrossRef]
- Yue, S.; He, H.; Li, B.; Hou, T. Hydrogel as a Biomaterial for Bone Tissue Engineering: A Review. Nanomaterials 2020, 10, 1511. [Google Scholar] [CrossRef] [PubMed]
- Chang, H.K.; Yang, D.H.; Ha, M.Y.; Kim, H.J.; Kim, C.H.; Kim, S.H.; Choi, J.W.; Chun, H.J. 3D Printing of Cell-Laden Visible Light Curable Glycol Chitosan Bioink for Bone Tissue Engineering. Carbohydr. Polym. 2022, 287, 119328. [Google Scholar] [CrossRef] [PubMed]
- Yang, H.; Jia, B.; Zhang, Z.; Qu, X.; Li, G.; Lin, W.; Zhu, D.; Dai, K.; Zheng, Y. Alloying Design of Biodegradable Zinc as Promising Bone Implants for Load-Bearing Applications. Nat. Commun. 2020, 11, 1–16. [Google Scholar] [CrossRef]
- Cadosch, D.; Chan, E.; Gautschi, O.P.; Filgueira, L. Metal Is Not Inert: Role of Metal Ions Released by Biocorrosion in Aseptic Loosening—Current Concepts. J. Biomed. Mater. Res. A 2009, 91, 1252–1262. [Google Scholar] [CrossRef]
- Gupta, S.; Gupta, H.; Tandan, A. Technical Complications of Implant-Causes and Management: A Comprehensive Review. Natl. J. Maxillofac. Surg. 2015, 6, 3. [Google Scholar] [CrossRef]
- Siti Nur Hazwani, M.R.; LIM, L.X.; Lockman, Z.; Zuhailawati, H. Fabrication of Titanium-Based Alloys with Bioactive Surface Oxide Layer as Biomedical Implants: Opportunity and Challenges. Trans. Nonferrous Met. Soc. China 2022, 32, 1–44. [Google Scholar] [CrossRef]
- Hermawan, H.; Ramdan, D.; Djuansjah, J.R.P. Metals for Biomedical Applications. In Biomedical Engineering—From Theory to Applications; InTech: Rijeka, Croatia, 2011. [Google Scholar] [CrossRef]
- Hanawa, T. Research and Development of Metals for Medical Devices Based on Clinical Needs. Sci. Technol. Adv. Mater. 2012, 13. [Google Scholar] [CrossRef] [PubMed]
- Ma, L.; Wiame, F.; Maurice, V.; Marcus, P. Origin of Nanoscale Heterogeneity in the Surface Oxide Film Protecting Stainless Steel against Corrosion. npj Mater. Degrad. 2019, 3, 1–9. [Google Scholar] [CrossRef]
- Marcolongo, M.; Sarkar, S.; Ganesh, N. 7.11 Trends in Materials for Spine Surgery. Compr. Biomater. II 2017, 175–198. [Google Scholar] [CrossRef]
- Yan, X.; Cao, W.; Li, H. Biomedical Alloys and Physical Surface Modifications: A Mini-Review. Materials 2021, 15, 66. [Google Scholar] [CrossRef]
- Li, M.; Yin, T.; Wang, Y.; Du, F.; Zou, X.; Gregersen, H.; Wang, G. Study of Biocompatibility of Medical Grade High Nitrogen Nickel-Free Austenitic Stainless Steel in Vitro. Mater. Sci. Eng. C 2014, 43, 641–648. [Google Scholar] [CrossRef]
- Niinomi, M.; Liu, Y.; Nakai, M.; Liu, H.; Li, H. Biomedical Titanium Alloys with Young’s Moduli Close to That of Cortical Bone. Regen. Biomater. 2016, 3, 173. [Google Scholar] [CrossRef]
- Li, Y.; Yang, C.; Zhao, H.; Qu, S.; Li, X.; Li, Y. New Developments of Ti-Based Alloys for Biomedical Applications. Materials 2014, 7, 1709. [Google Scholar] [CrossRef]
- Noyama, Y.; Miura, T.; Ishimoto, T.; Itaya, T.; Niinomi, M.; Nakano, T. Bone Loss and Reduced Bone Quality of the Human Femur after Total Hip Arthroplasty under Stress-Shielding Effects by Titanium-Based Implant. Mater. Trans. 2012, 53, 565–570. [Google Scholar] [CrossRef]
- Plecko, M.; Sievert, C.; Andermatt, D.; Frigg, R.; Kronen, P.; Klein, K.; Stübinger, S.; Nuss, K.; Bürki, A.; Ferguson, S.; et al. Osseointegration and Biocompatibility of Different Metal Implants—A Comparative Experimental Investigation in Sheep. BMC Musculoskelet. Disord. 2012, 13, 32. [Google Scholar] [CrossRef]
- Garcia-Mendez, M.C.; Urrutia-Baca, V.H.; Cuao-Moreu, C.A.; Lorenzo-Bonet, E.; Alvarez-Vera, M.; Ortiz-Martinez, D.M.; de la Garza-Ramos, M.A. In Vitro Biocompatibility Evaluation of a New Co-Cr-B Alloy with Potential Biomedical Application. Metals 2021, 11, 1267. [Google Scholar] [CrossRef]
- Marti, A. Cobalt-Base Alloys Used in Surgery. Injury 2000, 31. [Google Scholar] [CrossRef]
- Yu, W.; Li, X.; Ma, X.; Xu, X. Biomechanical Analysis of Inclined and Cantilever Design with Different Implant Framework Materials in Mandibular Complete-Arch Implant Restorations. J. Prosthet. Dent. 2022. [Google Scholar] [CrossRef] [PubMed]
- Kaivosoja, E.; Tiainen, V.-M.; Takakubo, Y.; Rajchel, B.; Sobiecki, J.; Konttinen, Y.T.; Takagi, M. Materials Used for Hip and Knee Implants. Wear Orthop. Implant. Artif. Jt. 2013, 178–218. [Google Scholar] [CrossRef]
- Nine, M.J.; Choudhury, D.; Hee, A.C.; Mootanah, R.; Osman, N.A.A. Wear Debris Characterization and Corresponding Biological Response: Artificial Hip and Knee Joints. Materials 2014, 7, 980. [Google Scholar] [CrossRef] [PubMed]
- González-Mora, V.A.; Hoffmann, M.; Stroosnijder, R.; Espinar, E.; Llamas, J.M.; Fernández-Fairén, M.; Gil, F.J. Influence of Different CoCrMo Counterfaces on Wear in UHMWPE for Artificial Joints. J. Biomed. Sci. Eng. 2011, 4, 375–382. [Google Scholar] [CrossRef][Green Version]
- Briffa, J.; Sinagra, E.; Blundell, R. Heavy Metal Pollution in the Environment and Their Toxicological Effects on Humans. Heliyon 2020, 6, e04691. [Google Scholar] [CrossRef]
- Jaishankar, M.; Tseten, T.; Anbalagan, N.; Mathew, B.B.; Beeregowda, K.N. Toxicity, Mechanism and Health Effects of Some Heavy Metals. Interdiscip. Toxicol. 2014, 7, 60. [Google Scholar] [CrossRef]
- Genchi, G.; Carocci, A.; Lauria, G.; Sinicropi, M.S.; Catalano, A. Nickel: Human Health and Environmental Toxicology. Int. J. Environ. Res. Public Health 2020, 17, 679. [Google Scholar] [CrossRef]
- Guo, Z.; Pang, X.; Yan, Y.; Gao, K.; Volinsky, A.A.; Zhang, T.Y. CoCrMo Alloy for Orthopedic Implant Application Enhanced Corrosion and Tribocorrosion Properties by Nitrogen Ion Implantation. Appl. Surf. Sci. 2015, 347, 23–34. [Google Scholar] [CrossRef]
- Liu, R.; Li, X.; Hu, X.; Dong, H. Surface Modification of a Medical Grade Co-Cr-Mo Alloy by Low-Temperature Plasma Surface Alloying with Nitrogen and Carbon. Surf. Coat. Technol. 2013, 232, 906–911. [Google Scholar] [CrossRef]
- Lourenço, M.L.; Cardoso, G.C.; Sousa, K.d.S.J.; Donato, T.A.G.; Pontes, F.M.L.; Grandini, C.R. Development of Novel Ti-Mo-Mn Alloys for Biomedical Applications. Sci. Rep. 2020, 10, 1–8. [Google Scholar] [CrossRef] [PubMed]
- Wilson, J. Metallic Biomaterials: State of the Art and New Challenges. Fundam. Biomater. Met. 2018, 1–33. [Google Scholar] [CrossRef]
- Sarraf, M.; Rezvani Ghomi, E.; Alipour, S.; Ramakrishna, S.; Liana Sukiman, N. A State-of-the-Art Review of the Fabrication and Characteristics of Titanium and Its Alloys for Biomedical Applications. Bio-Des. Manuf. 2021, 1, 1–25. [Google Scholar] [CrossRef] [PubMed]
- Estrin, Y.; Kim, H.E.; Lapovok, R.; Ng, H.P.; Jo, J.H. Mechanical Strength and Biocompatibility of Ultrafine-Grained Commercial Purity Titanium. BioMed Res. Int. 2013, 2013. [Google Scholar] [CrossRef] [PubMed]
- Farooq, M.U.; Mughal, M.P.; Ahmed, N.; Mufti, N.A.; Al-Ahmari, A.M.; He, Y. On the Investigation of Surface Integrity of Ti6Al4V ELI Using Si-Mixed Electric Discharge Machining. Materials 2020, 13, 1549. [Google Scholar] [CrossRef]
- Singh, N.; Hameed, P.; Ummethala, R.; Manivasagam, G.; Prashanth, K.G.; Eckert, J. Selective Laser Manufacturing of Ti-Based Alloys and Composites: Impact of Process Parameters, Application Trends, and Future Prospects. Mater. Today Adv. 2020, 8, 100097. [Google Scholar] [CrossRef]
- Elias, C.N.; Lima, J.H.C.; Valiev, R.; Meyers, M.A. Biomedical Applications of Titanium and Its Alloys. Jom 2008, 60, 46–49. [Google Scholar] [CrossRef]
- Lampman, S. Titanium and Its Alloys for Biomedical Implants. Mater. Med. Devices 2012, 223–236. [Google Scholar] [CrossRef]
- Martin, J.W. Metals and Alloys. Mater. Eng. 2006, 71–132. [Google Scholar] [CrossRef]
- Khadija, G.; Saleem, A.; Akhtar, Z.; Naqvi, Z.; Gull, M.; Masood, M.; Mukhtar, S.; Batool, M.; Saleem, N.; Rasheed, T.; et al. Short Term Exposure to Titanium, Aluminum and Vanadium (Ti 6Al 4V) Alloy Powder Drastically Affects Behavior and Antioxidant Metabolites in Vital Organs of Male Albino Mice. Toxicol. Rep. 2018, 5, 765–770. [Google Scholar] [CrossRef] [PubMed]
- Costa, B.C.; Tokuhara, C.K.; Rocha, L.A.; Oliveira, R.C.; Lisboa-Filho, P.N.; Costa Pessoa, J. Vanadium Ionic Species from Degradation of Ti-6Al-4V Metallic Implants: In Vitro Cytotoxicity and Speciation Evaluation. Mater. Sci. Eng. C 2019, 96, 730–739. [Google Scholar] [CrossRef] [PubMed]
- Han, X.; Ji, X.; Zhao, M.; Li, D. Mg/Ag Ratios Induced in Vitro Cell Adhesion and Preliminary Antibacterial Properties of TiN on Medical Ti-6Al-4V Alloy by Mg and Ag Implantation. Surf. Coat. Technol. 2020, 397, 126020. [Google Scholar] [CrossRef]
- Chlebus, E.; Kuźnicka, B.; Kurzynowski, T.; Dybała, B. Microstructure and Mechanical Behaviour of Ti-6Al-7Nb Alloy Produced by Selective Laser Melting. Mater. Charact. 2011, 62, 488–495. [Google Scholar] [CrossRef]
- Challa, V.S.A.; Mali, S.; Misra, R.D.K. Reduced Toxicity and Superior Cellular Response of Preosteoblasts to Ti-6Al-7Nb Alloy and Comparison with Ti-6Al-4V. J. Biomed. Mater. Res. Part A 2013, 101A, 2083–2089. [Google Scholar] [CrossRef] [PubMed]
- Lyczkowska, E.; Szymczyk, P.; Dybała, B.; Chlebus, E. Chemical Polishing of Scaffolds Made of Ti-6Al-7Nb Alloy by Additive Manufacturing. Arch. Civ. Mech. Eng. 2014, 14, 586–594. [Google Scholar] [CrossRef]
- Niu, Q.L.; Zheng, X.H.; Ming, W.W.; Chen, M. Friction and Wear Performance of Titanium Alloys against Tungsten Carbide under Dry Sliding and Water Lubrication. Tribol. Trans. 2013, 56, 101–108. [Google Scholar] [CrossRef]
- Fellah, M.; Labaïz, M.; Assala, O.; Dekhil, L.; Taleb, A.; Rezag, H.; Iost, A. Tribological Behavior of Ti-6Al-4V and Ti-6Al-7Nb Alloys for Total Hip Prosthesis. Adv. Tribol. 2014, 2014. [Google Scholar] [CrossRef]
- Delgado-Ruiz, R.; Romanos, G. Potential Causes of Titanium Particle and Ion Release in Implant Dentistry: A Systematic Review. Int. J. Mol. Sci. 2018, 19, 3585. [Google Scholar] [CrossRef]
- Shuai, C.; Li, S.; Peng, S.; Feng, P.; Lai, Y.; Gao, C. Biodegradable Metallic Bone Implants. Mater. Chem. Front. 2019, 3, 544–562. [Google Scholar] [CrossRef]
- Harrison, R.; Maradze, D.; Lyons, S.; Zheng, Y.; Liu, Y. Corrosion of Magnesium and Magnesium–Calcium Alloy in Biologically-Simulated Environment. Prog. Nat. Sci. Mater. Int. 2014, 24, 539–546. [Google Scholar] [CrossRef]
- Amukarimi, S.; Mozafari, M. Biodegradable Magnesium-based Biomaterials: An Overview of Challenges and Opportunities. MedComm 2021, 2, 123. [Google Scholar] [CrossRef]
- Tsakiris, V.; Tardei, C.; Clicinschi, F.M. Biodegradable Mg Alloys for Orthopedic Implants—A Review. J. Magnes. Alloy. 2021, 9, 1884–1905. [Google Scholar] [CrossRef]
- Alam, M.E.; Pal, S.; Decker, R.; Ferreri, N.C.; Knezevic, M.; Beyerlein, I.J. Rare-Earth- and Aluminum-Free, High Strength Dilute Magnesium Alloy for Biomedical Applications. Sci. Rep. 2020, 10, 15839. [Google Scholar] [CrossRef] [PubMed]
- Prasad, S.V.S.; Prasad, S.B.; Verma, K.; Mishra, R.K.; Kumar, V.; Singh, S. The Role and Significance of Magnesium in Modern Day Research—A Review. J. Magnes. Alloy. 2022, 10, 1–61. [Google Scholar] [CrossRef]
- Loukil, N. Alloying Elements of Magnesium Alloys: A Literature Review. In Magnesium Alloys [Working Title]; InTech: Rijeka, Croatia, 2021. [Google Scholar] [CrossRef]
- Sezer, N.; Evis, Z.; Kayhan, S.M.; Tahmasebifar, A.; Koç, M. Review of Magnesium-Based Biomaterials and Their Applications. J. Magnes. Alloy. 2018, 6, 23–43. [Google Scholar] [CrossRef]
- Li, Q.; Wang, Q.; Wang, Y.; Zeng, X.; Ding, W. Effect of Nd and Y Addition on Microstructure and Mechanical Properties of As-Cast Mg-Zn-Zr Alloy. J. Alloys Compd. 2007, 427, 115–123. [Google Scholar] [CrossRef]
- Liu, C.; Ren, Z.; Xu, Y.; Pang, S.; Zhao, X.; Zhao, Y. Biodegradable Magnesium Alloys Developed as Bone Repair Materials: A Review. Scanning 2018, 2018. [Google Scholar] [CrossRef]
- Xu, Y.; Li, J.; Qi, M.; Liao, L.; Gao, Z. Enhanced Mechanical Properties of Mg-Zn-Y-Zr Alloy by Low-Speed Indirect Extrusion. J. Mater. Res. Technol. 2020, 9, 9856–9867. [Google Scholar] [CrossRef]
- Wang, S.; Han, Z.; Nie, Y.; Dai, J.; Li, X.; Cheng, J.; Zhang, X. Modified Mechanical Properties of Mg-Nd-Zn-Ag-Zr Alloy by Solution Treatment for Cardiovascular Stent Application. Mater. Res. Express 2019, 6, 085416. [Google Scholar] [CrossRef]
- Jamel, M.M.; Jamel, M.M.; Lopez, H.F. Designing Advanced Biomedical Biodegradable Mg Alloys: A Review. Metals 2022, 12, 85. [Google Scholar] [CrossRef]
- Ralls, A.; Kumar, P.; Misra, M.; Menezes, P.L. Material Design and Surface Engineering for Bio-Implants. JOM 2020, 72, 684–696. [Google Scholar] [CrossRef]
- Hussain, M.; Askari Rizvi, S.H.; Abbas, N.; Sajjad, U.; Shad, M.R.; Badshah, M.A.; Malik, A.I. Recent Developments in Coatings for Orthopedic Metallic Implants. Coatings 2021, 11, 791. [Google Scholar] [CrossRef]
- Prakasam, M.; Locs, J.; Salma-Ancane, K.; Loca, D.; Largeteau, A.; Berzina-Cimdina, L. Biodegradable Materials and Metallic Implants—A Review. J. Funct. Biomater. 2017, 8, 44. [Google Scholar] [CrossRef] [PubMed]
- Lam, M.; Migonney, V.; Falentin-Daudre, C. Review of Silicone Surface Modification Techniques and Coatings for Antibacterial/Antimicrobial Applications to Improve Breast Implant Surfaces. Acta Biomater. 2021, 121, 68–88. [Google Scholar] [CrossRef] [PubMed]
- Accioni, F.; Vázquez, J.; Merinero, M.; Begines, B.; Alcudia, A. Latest Trends in Surface Modification for Dental Implantology: Innovative Developments and Analytical Applications. Pharmaceutics 2022, 14, 455. [Google Scholar] [CrossRef] [PubMed]
- Sikder, P.; Ren, Y.; Bhaduri, S.B. Synthesis and Evaluation of Protective Poly(Lactic Acid) and Fluorine-Doped Hydroxyapatite–Based Composite Coatings on AZ31 Magnesium Alloy. J. Mater. Res. 2019, 34, 3766–3776. [Google Scholar] [CrossRef]
- Metroke, T.L.; Parkhill, R.L.; Knobbe, E.T. Passivation of Metal Alloys Using Sol–Gel-Derived Materials—A Review. Prog. Org. Coat. 2001, 41, 233–238. [Google Scholar] [CrossRef]
- Bekmurzayeva, A.; Duncanson, W.J.; Azevedo, H.S.; Kanayeva, D. Surface Modification of Stainless Steel for Biomedical Applications: Revisiting a Century-Old Material. Mater. Sci. Eng. C 2018, 93, 1073–1089. [Google Scholar] [CrossRef]
- Quinn, J.; McFadden, R.; Chan, C.W.; Carson, L. Titanium for Orthopedic Applications: An Overview of Surface Modification to Improve Biocompatibility and Prevent Bacterial Biofilm Formation. iScience 2020, 23, 101745. [Google Scholar] [CrossRef]
- Nilawar, S.; Uddin, M.; Chatterjee, K. Surface Engineering of Biodegradable Implants: Emerging Trends in Bioactive Ceramic Coatings and Mechanical Treatments. Mater. Adv. 2021, 2, 7820–7841. [Google Scholar] [CrossRef]
- Friedrich, K.; Zhang, Z.; Schlarb, A.K. Effects of Various Fillers on the Sliding Wear of Polymer Composites. Compos. Sci. Technol. 2005, 65, 2329–2343. [Google Scholar] [CrossRef]
- Almasi, D.; Iqbal, N.; Sadeghi, M.; Sudin, I.; Abdul Kadir, M.R.; Kamarul, T. Preparation Methods for Improving PEEK’s Bioactivity for Orthopedic and Dental Application: A Review. Int. J. Biomater. 2016, 2016. [Google Scholar] [CrossRef] [PubMed]
- Lu, Z.P.; Friedrich, K. On Sliding Friction and Wear of PEEK and Its Composites. Wear 1995, 181–183, 624–631. [Google Scholar] [CrossRef]
- Vande Voort, J.; Bahadur, S. The Growth and Bonding of Transfer Film and the Role of CuS and PTFE in the Tribological Behavior of PEEK. Wear 1995, 181–183, 212–221. [Google Scholar] [CrossRef]
- Zhang, G.; Leparoux, S.; Liao, H.; Coddet, C. Microwave Sintering of Poly-Ether-Ether-Ketone (PEEK) Based Coatings Deposited on Metallic Substrate. Scr. Mater. 2006, 55, 621–624. [Google Scholar] [CrossRef]
- Normand, B.; Takenouti, H.; Keddam, M.; Liao, H.; Monteil, G.; Coddet, C. Electrochemical Impedance Spectroscopy and Dielectric Properties of Polymer: Application to PEEK Thermally Sprayed Coating. Electrochim. Acta 2004, 49, 2981–2986. [Google Scholar] [CrossRef]
- Zhang, G.; Liao, H.; Yu, H.; Ji, V.; Huang, W.; Mhaisalkar, S.G.; Coddet, C. Correlation of Crystallization Behavior and Mechanical Properties of Thermal Sprayed PEEK Coating. Surf. Coat. Technol. 2006, 200, 6690–6695. [Google Scholar] [CrossRef]
- Fiołek, A.; Zimowski, S.; Kopia, A.; Łukaszczyk, A.; Moskalewicz, T. Electrophoretic Co-Deposition of Polyetheretherketone and Graphite Particles: Microstructure, Electrochemical Corrosion Resistance, and Coating Adhesion to a Titanium Alloy. Materials 2020, 13, 3251. [Google Scholar] [CrossRef]
- Sak, A.; Moskalewicz, T.; Zimowski, S.; Cieniek, Ł.; Dubiel, B.; Radziszewska, A.; Kot, M.; Łukaszczyk, A. Influence of Polyetheretherketone Coatings on the Ti-13Nb-13Zr Titanium Alloy’s Bio-Tribological Properties and Corrosion Resistance. Mater. Sci. Eng. C 2016, 63, 52–61. [Google Scholar] [CrossRef]
- Virk, R.S.; Ur Rehman, M.A.; Boccaccini, A.R. PEEK Based Biocompatible Coatings Incorporating H-BN and Bioactive Glass by Electrophoretic Deposition. ECS Trans. 2018, 82, 89–95. [Google Scholar] [CrossRef]
- Wu, X.; Liu, X.; Wei, J.; Ma, J.; Deng, F.; Wei, S. Nano-TiO2/PEEK Bioactive Composite as a Bone Substitute Material: In Vitro and in Vivo Studies. Int. J. Nanomed. 2012, 7, 1215–1225. [Google Scholar] [CrossRef]
- Moskalewicz, T.; Zych, A.; Łukaszczyk, A.; Cholewa-Kowalska, K.; Kruk, A.; Dubiel, B.; Radziszewska, A.; Berent, K.; Gajewska, M. Electrophoretic Deposition, Microstructure, and Corrosion Resistance of Porous Sol–Gel Glass/Polyetheretherketone Coatings on the Ti-13Nb-13Zr Alloy. Metall. Mater. Trans. A Phys. Metall. Mater. Sci. 2017, 48, 2660–2673. [Google Scholar] [CrossRef][Green Version]
- Atiq Ur Rehman, M.; Bastan, F.E.; Haider, B.; Boccaccini, A.R. Electrophoretic Deposition of PEEK/Bioactive Glass Composite Coatings for Orthopedic Implants: A Design of Experiments (DoE) Study. Mater. Des. 2017, 130, 223–230. [Google Scholar] [CrossRef]
- Lebga-Nebane, J.L.; Sankarasubramanian, M.; Chojecki, G.; Ning, B.; Yuya, P.A.; Moosbrugger, J.C.; Rasmussen, D.H.; Krishnan, S. Polyetheretherketone, Hexagonal Boron Nitride, and Tungsten Carbide Cobalt Chromium Composite Coatings: Mechanical and Tribological Properties. J. Appl. Polym. Sci. 2021, 138, 50504. [Google Scholar] [CrossRef]
- Seuss, S.; Heinloth, M.; Boccaccini, A.R. Development of Bioactive Composite Coatings Based on Combination of PEEK, Bioactive Glass and Ag Nanoparticles with Antibacterial Properties. Surf. Coat. Technol. 2016, 301, 100–105. [Google Scholar] [CrossRef]
- Garrido, B.; Albaladejo-Fuentes, V.; Cano, I.G.; Dosta, S. Development of Bioglass/PEEK Composite Coating by Cold Gas Spray for Orthopedic Implants. J. Therm. Spray Technol. 2022, 1–11. [Google Scholar] [CrossRef]
- Torres, Y.; Romero, C.; Chen, Q.; Pérez, G.; Rodríguez-Ortiz, J.A.; Pavón, J.J.; Álvarez, L.; Arévalo, C.; Boccaccini, A.R. Electrophoretic Deposition of PEEK/45S5 Bioactive Glass Coating on Porous Titanium Substrate: Influence of Processing Conditions and Porosity Parameters. Key Eng. Mater. 2016, 704, 343–350. [Google Scholar] [CrossRef]
- Tharajak, J.; Palathai, T.; Sombatsompop, N. Morphological and Physical Properties and Friction/Wear Behavior of h-BN Filled PEEK Composite Coatings. Surf. Coat. Technol. 2015, 273, 20–29. [Google Scholar] [CrossRef]
- Moskalewicz, T.; Zimowski, S.; Zych, A.; Łukaszczyk, A.; Reczyńska, K.; Pamuła, E. Electrophoretic Deposition, Microstructure and Selected Properties of Composite Alumina/Polyetheretherketone Coatings on the Ti-13Nb-13Zr Alloy. J. Electrochem. Soc. 2018, 165, D116–D128. [Google Scholar] [CrossRef]
- Moskalewicz, T.; Zych, A.; Kruk, A.; Kopia, A.; Zimowski, S.; Sitarz, M.; Cieniek, Ł. Electrophoretic Deposition and Microstructure Development of Si3N4/Polyetheretherketone Coatings on Titanium Alloy. Surf. Coat. Technol. 2018, 350, 633–647. [Google Scholar] [CrossRef]
- Baştan, F.E.; Atiq Ur Rehman, M.; Avcu, Y.Y.; Avcu, E.; Üstel, F.; Boccaccini, A.R. Electrophoretic Co-Deposition of PEEK-Hydroxyapatite Composite Coatings for Biomedical Applications. Colloids Surf. B Biointerfaces 2018, 169, 176–182. [Google Scholar] [CrossRef] [PubMed]
- Lee, J.H.; Jang, H.L.; Lee, K.M.; Baek, H.R.; Jin, K.; Noh, J.H. Cold-Spray Coating of Hydroxyapatite on a Three-Dimensional Polyetheretherketone Implant and Its Biocompatibility Evaluated by in Vitro and in Vivo Minipig Model. J. Biomed. Mater. Res.-Part B Appl. Biomater. 2017, 105, 647–657. [Google Scholar] [CrossRef] [PubMed]
- Kadiyala, A.K.; Bijwe, J.; Kalappa, P. Investigations on Influence of Nano and Micron Sized Particles of SiC on Performance Properties of PEEK Coatings. Surf. Coat. Technol. 2018, 334, 124–133. [Google Scholar] [CrossRef]
- Abdulkareem, M.H.; Abdalsalam, A.H.; Bohan, A.J. Influence of Chitosan on the Antibacterial Activity of Composite Coating (PEEK /HAp) Fabricated by Electrophoretic Deposition. Prog. Org. Coat. 2019, 130, 251–259. [Google Scholar] [CrossRef]
- Chen, X.; Ma, R.; Min, J.; Li, Z.; Yu, P.; Yu, H. Effect of PEEK and PTFE Coatings in Fatigue Performance of Dental Implant Retaining Screw Joint: An in Vitro Study. J. Mech. Behav. Biomed. Mater. 2020, 103. [Google Scholar] [CrossRef]
- Song, J.; Liao, Z.; Shi, H.; Xiang, D.; Xu, L.; Liu, Y.; Mu, X.; Liu, W. Blood Compatibility of ZrO2 Particle Reinforced PEEK Coatings on Ti6Al4V Substrates. Polymers 2017, 9, 589. [Google Scholar] [CrossRef]
- Song, J.; Liao, Z.; Wang, S.; Liu, Y.; Liu, W.; Tyagi, R. Study on the Tribological Behaviors of Different PEEK Composite Coatings for Use as Artificial Cervical Disk Materials. J. Mater. Eng. Perform. 2016, 25, 116–129. [Google Scholar] [CrossRef]
- Xie, C.; Li, P.; Liu, Y.; Luo, F.; Xiao, X. Preparation of TiO2 Nanotubes/Mesoporous Calcium Silicate Composites with Controllable Drug Release. Mater. Sci. Eng. C Mater. Biol. Appl. 2016, 67, 433–439. [Google Scholar] [CrossRef]
- Pradhan, D.; Wren, A.W.; Misture, S.T.; Mellott, N.P. Investigating the Structure and Biocompatibility of Niobium and Titanium Oxides as Coatings for Orthopedic Metallic Implants. Mater. Sci. Eng. C 2016, 58, 918–926. [Google Scholar] [CrossRef]
- Mirak, M.; Alizadeh, M.; Ashtiani, M.N. Characterization, Mechanical Properties and Corrosion Resistance of Biocompatible Zn-HA/TiO2 Nanocomposite Coatings. J. Mech. Behav. Biomed. Mater. 2016, 62, 282–290. [Google Scholar] [CrossRef] [PubMed]
- Cao, Y.Q.; Zi, T.Q.; Zhao, X.R.; Liu, C.; Ren, Q.; Fang, J.B.; Li, W.M.; Li, A.D. Enhanced Visible Light Photocatalytic Activity of Fe2O3 Modified TiO2 Prepared by Atomic Layer Deposition. Sci. Rep. 2020, 10, 1–10. [Google Scholar] [CrossRef] [PubMed]
- He, X.; Zhang, G.; Zhang, H.; Hang, R.; Huang, X.; Yao, X.; Zhang, X. Cu and Si Co-Doped Microporous TiO2 Coating for Osseointegration by the Coordinated Stimulus Action. Appl. Surf. Sci. 2020, 503, 144072. [Google Scholar] [CrossRef]
- Gartner, M.; Trapalis, C.; Todorova, N.; Giannakopoulou, T.; Dobrescu, G.; Anastasescu, M.; Osiceanu, P.; Ghita, A.; Enache, M.; Dumitru, L.; et al. Doped Sol-Gel TiO2 Films for Biological Applications. Bull. Korean Chem. Soc. 2008, 29, 1038–1042. [Google Scholar] [CrossRef]
- Radeka, M.; Markov, S.; Lončar, E.; Rudić, O.; Vučetić, S.; Ranogajec, J. Photocatalytic Effects of TiO2 Mesoporous Coating Immobilized on Clay Roofing Tiles. J. Eur. Ceram. Soc. 2014, 34, 127–136. [Google Scholar] [CrossRef]
- Park, S.; Park, J.; Heo, J.; Hong, B.Y.; Hong, J. Growth Behaviors and Biocidal Properties of Titanium Dioxide Films Depending on Nucleation Duration in Liquid Phase Deposition. Appl. Surf. Sci. 2017, 425, 547–552. [Google Scholar] [CrossRef]
- Hamza, R.Z.; Gobouri, A.A.; Al-Yasi, H.M.; Al-Talhi, T.A.; El-Megharbel, S.M. A New Sterilization Strategy Using TiO2 Nanotubes for Production of Free Radicals That Eliminate Viruses and Application of a Treatment Strategy to Combat Infections Caused by Emerging SARS-CoV-2 during the COVID-19 Pandemic. Coatings 2021, 11, 680. [Google Scholar] [CrossRef]
- Zhang, S.; Liang, X.; Gadd, G.M.; Zhao, Q. Advanced Titanium Dioxide-Polytetrafluorethylene (TiO2-PTFE) Nanocomposite Coatings on Stainless Steel Surfaces with Antibacterial and Anti-Corrosion Properties. Appl. Surf. Sci. 2019, 490, 231–241. [Google Scholar] [CrossRef]
- Yetim, T. Corrosion Behavior of Ag-Doped TiO2 Coatings on Commercially Pure Titanium in Simulated Body Fluid Solution. J. Bionic Eng. 2016, 13, 397–405. [Google Scholar] [CrossRef]
- Moongraksathum, B.; Chien, M.-Y.; Chen, Y.-W. Antiviral and Antibacterial Effects of Silver-Doped TiO 2 Prepared by the Peroxo Sol-Gel Method. J. Nanosci. Nanotechnol. 2019, 19, 7356–7362. [Google Scholar] [CrossRef]
- Hua, Z.; Zhang, C.; Xu, Y.; Jia, H.; Chen, X.; Bai, Y.; Wei, B. Efficiently Reduced Heat Rise in TiO 2 Coating Ti-Based Metallic Implants Using Anodic Oxidation Method. Surf. Coat. Technol. 2019, 363, 75–79. [Google Scholar] [CrossRef]
- Xian, P.; Chen, Y.; Gao, S.; Qian, J.; Zhang, W.; Udduttula, A.; Huang, N.; Wan, G. Polydopamine (PDA) Mediated Nanogranular-Structured Titanium Dioxide (TiO2) Coating on Polyetheretherketone (PEEK) for Oral and Maxillofacial Implants Application. Surf. Coat. Technol. 2020, 401. [Google Scholar] [CrossRef]
- Chai, M.; An, M.; Zhang, X. Construction of a TiO2/MoSe2/CHI Coating on Dental Implants for Combating Streptococcus Mutans Infection. Mater. Sci. Eng. C 2021, 129. [Google Scholar] [CrossRef] [PubMed]
- Kiran, A.S.K.; Kumar, T.S.S.; Sanghavi, R.; Doble, M.; Ramakrishna, S. Antibacterial and Bioactive Surface Modifications of Titanium Implants by PCL/TiO2 Nanocomposite Coatings. Nanomaterials 2018, 8, 860. [Google Scholar] [CrossRef] [PubMed]
- Doll, P.W.; Ahrens, R.; Guber, A.E. Etch-Less Microfabrication of Structured TiO2 Implant Coatings on Bulk Titanium Grade 23 by Direct Lithographic Anodic Oxidation. J. Micromech. Microeng. 2021, 31. [Google Scholar] [CrossRef]
- Zhu, Y.; Zheng, T.; Wen, L.M.; Li, R.; Zhang, Y.B.; Bi, W.J.; Feng, X.J.; Qi, M.C. Osteogenic Capability of Strontium and Icariin-Loaded TiO2 Nanotube Coatings in Vitro and in Osteoporotic Rats. J. Biomater. Appl. 2021, 35, 1119–1131. [Google Scholar] [CrossRef] [PubMed]
- Long, X.; Duan, L.; Weng, W.; Cheng, K.; Wang, D.; Ouyang, H. Light-Induced Osteogenic Differentiation of BMSCs with Graphene/TiO2 Composite Coating on Ti Implant. Colloids Surf. B Biointerfaces 2021, 207. [Google Scholar] [CrossRef]
- Visentin, F.; el Habra, N.; Fabrizio, M.; Brianese, N.; Gerbasi, R.; Nodari, L.; Zin, V.; Galenda, A. TiO2-HA Bi-Layer Coatings for Improving the Bioactivity and Service-Life of Ti Dental Implants. Surf. Coat. Technol. 2019, 378. [Google Scholar] [CrossRef]
- Zhang, B.; Li, B.; Gao, S.; Li, Y.; Cao, R.; Cheng, J.; Li, R.; Wang, E.; Guo, Y.; Zhang, K.; et al. Y-Doped TiO2 Coating with Superior Bioactivity and Antibacterial Property Prepared via Plasma Electrolytic Oxidation. Mater. Des. 2020, 192. [Google Scholar] [CrossRef]
- Li, K.; Liu, S.; Xue, Y.; Zhang, L.; Han, Y. A Superparamagnetic Fe3O4-TiO2 Composite Coating on Titanium by Micro-Arc Oxidation for Percutaneous Implants. J. Mater. Chem. B 2019, 7, 5265–5276. [Google Scholar] [CrossRef]
- Gobbi, S.J. Orthopedic Implants: Coating with TiN. Biomed. J. Sci. Tech. Res. 2019, 16. [Google Scholar] [CrossRef]
- Pogrebnjak, A.D.; Kong, C.H.; Webster, R.F.; Tilley, R.D.; Takeda, Y.; Oyoshi, K.; Bondar, O.V.; Buranich, V.V.; Konstantinov, S.V.; Baimoldanova, L.S.; et al. Antibacterial Effect of Au Implantation in Ductile Nanocomposite Multilayer (TiAlSiY)N/CrN Coatings. ACS Appl. Mater. Interfaces 2019, 11, 48540–48550. [Google Scholar] [CrossRef] [PubMed]
- Kim, H.; Kim, C.Y.; Kim, D.W.; Lee, I.S.; Lee, G.H.; Park, J.C.; Lee, S.J.; Lee, K.Y. Wear Performance of Self-Mating Contact Pairs of TiN and TiAlN Coatings on Orthopedic Grade Ti-6Al-4V. Biomed. Mater. 2010, 5, 044108. [Google Scholar] [CrossRef] [PubMed]
- Subramanian, B.; Muraleedharan, C.V.; Ananthakumar, R.; Jayachandran, M. A Comparative Study of Titanium Nitride (TiN), Titanium Oxy Nitride (TiON) and Titanium Aluminum Nitride (TiAlN), as Surface Coatings for Bio Implants. Surf. Coat. Technol. 2011, 205, 5014–5020. [Google Scholar] [CrossRef]
- Van Hove, R.P.; Sierevelt, I.N.; van Royen, B.J.; Nolte, P.A. Titanium-Nitride Coating of Orthopaedic Implants: A Review of the Literature. BioMed Res. Int. 2015, 2015. [Google Scholar] [CrossRef] [PubMed]
- Dion, I.; Baquey, C.; Candelon, B.; Monties, J.R. Hemocompatibility of Titanium Nitride. Int. J. Artif. Organs 1992, 15, 617–621. [Google Scholar] [CrossRef]
- Çomaklı, O. Improved Structural, Mechanical, Corrosion and Tribocorrosion Properties of Ti45Nb Alloys by TiN, TiAlN Monolayers, and TiAlN/TiN Multilayer Ceramic Films. Ceram. Int. 2021, 47, 4149–4156. [Google Scholar] [CrossRef]
- Dinu, M.; Pana, I.; Scripca, P.; Sandu, I.G.; Vitelaru, C.; Vladescu, A. Improvement of CoCr Alloy Characteristics by Ti-Based Carbonitride Coatings Used in Orthopedic Applications. Coatings 2020, 10, 495. [Google Scholar] [CrossRef]
- Ul-Hamid, A. Microstructure, Properties and Applications of Zr-Carbide, Zr-Nitride and Zr-Carbonitride Coatings: A Review. Mater. Adv. 2020, 1, 1012–1037. [Google Scholar] [CrossRef]
- Ghufran, M.; Uddin, G.M.; Arafat, S.M.; Jawad, M.; Rehman, A. Development and Tribo-Mechanical Properties of Functional Ternary Nitride Coatings: Applications-Based Comprehensive Review. Proc. Inst. Mech. Eng. Part J J. Eng. Tribol. 2020, 235, 196–232. [Google Scholar] [CrossRef]
- Chen, S.N.; Zhao, Y.M.; Zhang, Y.F.; Chen, L.; Liao, B.; Zhang, X.; Ouyang, X.P. Influence of Carbon Content on the Structure and Tribocorrosion Properties of TiAlCN/TiAlN/TiAl Multilayer Composite Coatings. Surf. Coat. Technol. 2021, 411, 126886. [Google Scholar] [CrossRef]
- Hovsepian, P.E.; Ehiasarian, A.P.; Petrov, I. TiAlCN/VCN Nanolayer Coatings Suitable for Machining of Al and Ti Alloys Deposited by Combined High Power Impulse Magnetron Sputtering/Unbalanced Magnetron Sputtering. Surf. Eng. 2013, 26, 610–614. [Google Scholar] [CrossRef]
- Caicedo, J.C.; Amaya, C.; Yate, L.; Gómez, M.E.; Zambrano, G.; Alvarado-Rivera, J.; Muñoz-Saldaña, J.; Prieto, P. TiCN/TiNbCN Multilayer Coatings with Enhanced Mechanical Properties. Appl. Surf. Sci. 2010, 256, 5898–5904. [Google Scholar] [CrossRef]
- Rajak, D.K.; Kumar, A.; Behera, A.; Menezes, P.L. Diamond-Like Carbon (DLC) Coatings: Classification, Properties, and Applications. Appl. Sci. 2021, 11, 4445. [Google Scholar] [CrossRef]
- Moritz, Y.; Saringer, C.; Tkadletz, M.; Stark, A.; Schell, N.; Letofsky-Papst, I.; Czettl, C.; Pohler, M.; Schalk, N. Oxidation Behavior of Arc Evaporated TiSiN Coatings Investigated by In-Situ Synchrotron X-Ray Diffraction and HR-STEM. Surf. Coat. Technol. 2020, 404, 126632. [Google Scholar] [CrossRef]
- Parau, A.C.; Vitelaru, C.; Balaceanu, M.; Braic, V.; Constantin, L.R.; Braic, M.; Vladescu, A. TiSiC, TiSiC-Zr, and TiSiC-Cr Coatings—Corrosion Resistance and Tribological Performance in Saline Solution. Tribol. Trans. 2015, 59, 72–79. [Google Scholar] [CrossRef]
- Xie, X.; Li, J.; Dong, M.; Zhang, H.; Wang, L. Structure and Properties of TiSiCN Coatings with Different Bias Voltages by Arc Ion Plating. Surf. Topogr. Metrol. Prop. 2018, 6, 014003. [Google Scholar] [CrossRef]
- Lin, J.; Wei, R.; Ge, F.; Li, Y.; Zhang, X.; Huang, F.; Lei, M. TiSiCN and TiAlVSiCN Nanocomposite Coatings Deposited from Ti and Ti-6Al-4V Targets. Surf. Coat. Technol. 2018, 336, 106–116. [Google Scholar] [CrossRef]
- Varghese, V.; Ramesh, M.R.; Chakradhar, D.; Shaik, H. Characterisation and Performance Evaluation of TiSiN &TiAlSiN Coatings by RF Magnetron Sputtering Deposition during End Milling of Maraging Steel. Mater. Res. Express 2020, 6, 126440. [Google Scholar] [CrossRef]
- Vitu, T.; Polcar, T.; Cvrcek, L.; Novak, R.; Macak, J.; Vyskocil, J.; Cavaleiro, A. Structure and Tribology of Biocompatible Ti-C:H Coatings. Surf. Coat. Technol. 2008, 202, 5790–5793. [Google Scholar] [CrossRef]
- Wan, Q.; Liu, N.; Yang, B.; Liu, H.; Chen, Y. Influence of Si Content on Properties of Ti(1-x)SixN Coatings. J. Wuhan Univ. Technol.-Mater. Sci. Ed. 2019, 34, 774–780. [Google Scholar] [CrossRef]
- Yuan, Z.; Han, Y.; Zang, S.; Chen, J.; He, G.; Chai, Y.; Yang, Z.; Fu, Q. Damage Evolution Behavior of TiN/Ti Multilayer Coatings under High-Speed Impact Conditions. Surf. Coat. Technol. 2021, 426, 127807. [Google Scholar] [CrossRef]
- Zhu, L.; Feng, C.; Zhu, S.; Wang, F.; Yuan, J.; Wang, P. Comparison of CrN, AlN and TiN Diffusion Barriers on the Interdiffusion and Oxidation Behaviors of Ni+CrAlYSiN Nanocomposite Coatings. Crystals 2021, 11, 1333. [Google Scholar] [CrossRef]
- Liu, H.; Zhang, X.; Jin, S.; Zhao, Y.; Ren, L.; Yang, K. Effect of Copper-Doped Titanium Nitride Coating on Angiogenesis. Mater. Lett. 2020, 269, 127634. [Google Scholar] [CrossRef]
- Castro, J.D.; Lima, M.J.; Carvalho, I.; Henriques, M.; Carvalho, S. Cu Oxidation Mechanism on Cu-Zr(O)N Coatings: Role on Functional Properties. Appl. Surf. Sci. 2021, 555. [Google Scholar] [CrossRef]
- Pana, I.; Braic, V.; Dinu, M.; Massima Mouele, E.S.; Parau, A.C.; Petrik, L.F.; Braic, M. In Vitro Corrosion of Titanium Nitride and Oxynitride-Based Biocompatible Coatings Deposited on Stainless Steel. Coatings 2020, 10, 710. [Google Scholar] [CrossRef]
- Kaliaraj, G.S.; Kumar, N. Oxynitrides Decorated 316L SS for Potential Bioimplant Application. Mater. Res. Express 2018, 5, 036403. [Google Scholar] [CrossRef]
- Lee, D.B.; Lee, Y.C.; Kwon, S.C. High Temperature Oxidation of TiCrN Coatings Deposited on a Steel Substrate by Ion Plating. Surf. Coat. Technol. 2001, 141, 232–239. [Google Scholar] [CrossRef]
- Chiu, K.A.; Fu, C.W.; Fang, Y.S.; Do, T.H.; Shih, F.H.; Chang, L. Heteroepitaxial Growth and Microwave Plasma Annealing of DC Reactive Sputtering Deposited TiZrN Film on Si (100). Surf. Coat. Technol. 2020, 394, 125873. [Google Scholar] [CrossRef]
- Kaliaraj, G.S.; Vishwakarma, V.; Ramadoss, A.; Ramachandran, D.; Rabel, A.M. Corrosion, Haemocompatibility and Bacterial Adhesion Behavior of TiZrN-Coated 316L SS for Bioimplants. Bull. Mater. Sci. 2015, 38, 951–955. [Google Scholar] [CrossRef]
- Cui, W.; Qin, G.; Duan, J.; Wang, H. A Graded Nano-TiN Coating on Biomedical Ti Alloy: Low Friction Coefficient, Good Bonding and Biocompatibility. Mater. Sci. Eng. C 2017, 71, 520–528. [Google Scholar] [CrossRef] [PubMed]
- Hussein, M.A.; Adesina, A.Y.; Kumar, A.M.; Sorour, A.A.; Ankah, N.; Al-Aqeeli, N. Mechanical, in-Vitro Corrosion, and Tribological Characteristics of TiN Coating Produced by Cathodic Arc Physical Vapor Deposition on Ti20Nb13Zr Alloy for Biomedical Applications. Thin Solid Films 2020, 709. [Google Scholar] [CrossRef]
- Uddin, G.M.; Jawad, M.; Ghufran, M.; Saleem, M.W.; Raza, M.A.; Rehman, Z.U.; Arafat, S.M.; Irfan, M.; Waseem, B. Experimental Investigation of Tribo-Mechanical and Chemical Properties of TiN PVD Coating on Titanium Substrate for Biomedical Implants Manufacturing. Int. J. Adv. Manuf. Technol. 2019, 102, 1391–1404. [Google Scholar] [CrossRef]
- Beshchasna, N.; Ho, A.Y.K.; Saqib, M.; Kraśkiewicz, H.; Wasyluk, Ł.; Kuzmin, O.; Duta, O.C.; Ficai, D.; Trusca, R.D.; Ficai, A.; et al. Surface Evaluation of Titanium Oxynitride Coatings Used for Developing Layered Cardiovascular Stents. Mater. Sci. Eng. C 2019, 99, 405–416. [Google Scholar] [CrossRef]
- Banakh, O.; Moussa, M.; Matthey, J.; Pontearso, A.; Cattani-Lorente, M.; Sanjines, R.; Fontana, P.; Wiskott, A.; Durual, S. Sputtered Titanium Oxynitride Coatings for Endosseous Applications: Physical and Chemical Evaluation and First Bioactivity Assays. Appl. Surf. Sci. 2014, 317, 986–993. [Google Scholar] [CrossRef]
- Banaszek, K.; Klimek, L.; Zgorzynska, E.; Swarzynska, A.; Walczewska, A. Cytotoxicity of Titanium Carbonitride Coatings for Prostodontic Alloys with Different Amounts of Carbon and Nitrogen. Biomed. Mater. 2018, 13. [Google Scholar] [CrossRef]
- Huang, H.L.; Chang, Y.Y.; Liu, J.X.; Tsai, M.T.; Lai, C.H. Antibacterial Activity and Cell Compatibility of TiZrN, TiZrCN, and TiZr-Amorphous Carbon Coatings. Thin Solid Films 2015, 596, 111–117. [Google Scholar] [CrossRef]
- Constantin, L.; Braic, M.; Dinu, M.; Balaceanu, M.; Braic, V.; Farcau, C.; Vladescu, A. Effects of Zr, Nb, or Si Addition on the Microstructural, Mechanical, and Corrosion Resistance of TiCN Hard Coatings. Mater. Corros. 2016, 67, 929–938. [Google Scholar] [CrossRef]
- Zheng, L.; Zhao, L.; Xiong, W. Tribological Properties of TiAlN-Coated Cermets. Rare Met. 2009, 28, 57–62. [Google Scholar] [CrossRef]
- Miletić, A.; Panjan, P.; Čekada, M.; Kovačević, L.; Terek, P.; Kovač, J.; Dražič, G.; Škorić, B. Nanolayer CrAlN/TiSiN Coating Designed for Tribological Applications. Ceram. Int. 2021, 47, 2022–2033. [Google Scholar] [CrossRef]
- Sampath Kumar, T.; Vinoth Jebaraj, A.; Shankar, E.; Tamiloli, N.; Sivakumar, K. Metallurgical and Mechanical Characterization of TiCN/TiAlN and TiAlN/TiCN Bilayer Nitride Coatings. Surf. Interfaces 2019, 15, 256–264. [Google Scholar] [CrossRef]
- Chetcuti, R.; Dearnley, P.A.; Mazzonello, A.; Buhagiar, J.; Mallia, B. Tribocorrosion Response of Duplex Layered CoCrMoC/CrN and CrN/CoCrMoC Coatings on Implant Grade 316LVM Stainless Steel. Surf. Coat. Technol. 2020, 384. [Google Scholar] [CrossRef]
- Rathmann, L.; Rusche, T.; Hasselbruch, H.; Mehner, A.; Radel, T. Friction and Wear Characterization of LIPSS and TiN / DLC Variants. Appl. Surf. Sci. 2022, 584, 152654. [Google Scholar] [CrossRef]
- Islam, M.; Díaz Lantada, A.; Mager, D.; Korvink, J.G.; Islam, M.; Mager, D.; Korvink, J.G.; Lantada, A.D. Carbon-Based Materials for Articular Tissue Engineering: From Innovative Scaffolding Materials toward Engineered Living Carbon. Adv. Healthc. Mater. 2022, 11, 2101834. [Google Scholar] [CrossRef] [PubMed]
- More, R.B.; Haubold, A.D.; Bokros, J.C. Pyrolytic Carbon for Long-Term Medical Implants. In Biomaterials Science: An Introduction to Materials, 3rd ed.; Academic Press: Cambridge, MA, USA, 2013; pp. 209–222. [Google Scholar] [CrossRef]
- Ross, M.; Williams, D.; Couzens, G.; Klawitter, J. Pyrocarbon for Joint Replacement. Jt. Replace. Technol. 2021, 145–163. [Google Scholar] [CrossRef]
- Victoria Cabañas, M. Bioceramic Coatings for Medical Implants. Bio-Ceram. Clin. Appl. 2014, 249–289. [Google Scholar] [CrossRef]
- Ren, J.; Lv, C.; Duan, Y.; Zhang, Y.; Zhang, J. Microstructure and Ablation Performance of HfC/PyC Core-Shell Structure Nanowire-Reinforced Hf1-XZrxC Coating. J. Eur. Ceram. Soc. 2021, 41, 7450–7463. [Google Scholar] [CrossRef]
- Feng, S.L.; Yang, Y.G.; Bai, S.; Xu, L.; Yang, X.M.; Xia, H.H.; Zhou, X.T. Microstructure of a Pyrolytic Carbon Coating on a Nuclear Graphite Substrate IG-110. Xinxing Tan Cailiao/New Carbon Mater. 2015, 30, 275–281. [Google Scholar] [CrossRef]
- Adkinson, J.M.; Chung, K.C. Advances in Small Joint Arthroplasty of the Hand. Plast. Reconstr. Surg. 2014, 134, 1260. [Google Scholar] [CrossRef]
- Nistor, P.A.; May, P.W. Diamond Thin Films: Giving Biomedical Applications a New Shine. J. R. Soc. Interface 2017, 14. [Google Scholar] [CrossRef]
- Catledge, S.A.; Thomas, V.; Vohra, Y.K. Nanostructured Diamond Coatings for Orthopaedic Applications. Woodhead Publ. Ser. Biomater. 2013, 2013, 105. [Google Scholar] [CrossRef] [PubMed]
- Medina, O.; Nocua, J.; Mendoza, F.; Gómez-Moreno, R.; Ávalos, J.; Rodríguez, C.; Morell, G. Bactericide and Bacterial Anti-Adhesive Properties of the Nanocrystalline Diamond Surface. Diam. Relat. Mater. 2012, 22, 77–81. [Google Scholar] [CrossRef]
- Siddiqui, S.; Dutta, G.; Tan, C.; Arumugam, P.U. Nanocrystalline Diamond Electrodes: Enabling Electrochemical Microsensing Applications with High Reliability and Stability. IEEE Nanotechnol. Mag. 2016, 10, 12. [Google Scholar] [CrossRef] [PubMed]
- Roy, R.K.; Lee, K.R. Biomedical Applications of Diamond-like Carbon Coatings: A Review. J. Biomed. Mater. Res. B Appl. Biomater. 2007, 83, 72–84. [Google Scholar] [CrossRef]
- Peng, F.; Lin, Y.; Zhang, D.; Ruan, Q.; Tang, K.; Li, M.; Liu, X.; Chu, P.K.; Zhang, Y. Corrosion Behavior and Biocompatibility of Diamond-like Carbon-Coated Zinc: An in Vitro Study. ACS Omega 2021, 6, 9843–9851. [Google Scholar] [CrossRef]
- Bean, P.A.; Evans, M.D.; Bendavid, A. Biomineralization of Osteoblasts on DLC Coated Surfaces for Bone Implants. Biointerphases 2018, 13, 041002. [Google Scholar] [CrossRef]
- Liu, J.; Wang, X.; Wu, B.J.; Zhang, T.F.; Leng, Y.X.; Huang, N. Tribocorrosion Behavior of DLC-Coated CoCrMo Alloy in Simulated Biological Environment. Vacuum 2013, 92, 39–43. [Google Scholar] [CrossRef]
- Mo, S.; Zhao, F.; Gao, A.; Wu, Y.; Liao, Q.; Xie, L.; Pan, H.; Tong, L.; Chu, P.K.; Wang, H. Simultaneous Application of Diamond-like Carbon Coating and Surface Amination on Polyether Ether Ketone: Towards Superior Mechanical Performance and Osseointegration. Smart Mater. Med. 2021, 2, 219–228. [Google Scholar] [CrossRef]
- Park, S.J.; Lee, K.R.; Ahn, S.H.; Kim, J.G. Instability of Diamond-like Carbon (DLC) Films during Sliding in Aqueous Environment. Diam. Relat. Mater. 2008, 17, 247–251. [Google Scholar] [CrossRef]
- Lung, B.H.; Chiang, M.J.; Hon, M.H. Effect of Gradient A-SiCx Interlayer on Adhesion of DLC Films. Mater. Chem. Phys. 2001, 72, 163–166. [Google Scholar] [CrossRef]
- Kumar, P.; Babu, P.D.; Mohan, L.; Anandan, C.; Grips, V.K.W. Wear and Corrosion Behavior of Zr-Doped DLC on Ti-13Zr-13Nb Biomedical Alloy. J. Mater. Eng. Perform. 2013, 22, 283–293. [Google Scholar] [CrossRef]
- Hauert, R. DLC Films in Biomedical Applications. Tribol. Diam.-Like Carbon Film. Fundam. Appl. 2008, 494–509. [Google Scholar] [CrossRef]
- Hatem, A.; Lin, J.; Wei, R.; Torres, R.D.; Laurindo, C.; Soares, P. Tribocorrosion Behavior of DLC-Coated Ti-6Al-4V Alloy Deposited by PIID and PEMS + PIID Techniques for Biomedical Applications. Surf. Coat. Technol. 2017, 332, 223–232. [Google Scholar] [CrossRef]
- Joshi, P.; Riley, P.R.; Denning, W.; Shukla, S.; Khosla, N.; Narayan, J.; Narayan, R. Laser-Patterned Carbon Coatings on Flexible and Optically Transparent Plastic Substrates for Advanced Biomedical Sensing and Implant Applications. J. Mater. Chem. C 2022. [Google Scholar] [CrossRef]
- López, R.; Menéndez, M.; Fernández, C.; Chmiela, A.; Bernardo-Sánchez, A. The Influence of Carbon Coatings on the Functional Properties of X39CR13 and 316LVM Steels Intended for Biomedical Applications. Metals 2019, 9, 815. [Google Scholar] [CrossRef]
- Awaja, F.; Cools, P.; Lohberger, B.; Nikiforov, A.Y.; Speranza, G.; Morent, R. Functionalized, Biocompatible, and Impermeable Nanoscale Coatings for PEEK. Mater. Sci. Eng. C 2017, 76, 865–870. [Google Scholar] [CrossRef] [PubMed]
- Choudhury, D.; Lackner, J.; Fleming, R.A.; Goss, J.; Chen, J.; Zou, M. Diamond-like Carbon Coatings with Zirconium-Containing Interlayers for Orthopedic Implants. J. Mech. Behav. Biomed. Mater. 2017, 68, 51–61. [Google Scholar] [CrossRef]
- Bociaga, D.; Sobczyk-Guzenda, A.; Komorowski, P.; Balcerzak, J.; Jastrzebski, K.; Przybyszewska, K.; Kaczmarek, A. Surface Characteristics and Biological Evaluation of Si-DLC Coatings Fabricated Using Magnetron Sputtering Method on Ti6Al7Nb Substrate. Nanomaterials 2019, 9, 812. [Google Scholar] [CrossRef]
- Rothammer, B.; Neusser, K.; Marian, M.; Bartz, M.; Krauß, S.; Böhm, T.; Thiele, S.; Merle, B.; Detsch, R.; Wartzack, S. Amorphous Carbon Coatings for Total Knee Replacements—Part I: Deposition, Cytocompatibility, Chemical and Mechanical Properties. Polymers 2021, 13, 1952. [Google Scholar] [CrossRef]
- Bociaga, D.; Sobczyk-Guzenda, A.; Szymanski, W.; Jedrzejczak, A.; Jastrzebska, A.; Olejnik, A.; Swiatek, L.; Jastrzebski, K. Diamond like Carbon Coatings Doped by Si Fabricated by a Multi-Target DC-RF Magnetron Sputtering Method—Mechanical Properties, Chemical Analysis and Biological Evaluation. Vacuum 2017, 143, 395–406. [Google Scholar] [CrossRef]
- Derakhshandeh, M.R.; Eshraghi, M.J.; Hadavi, M.M.; Javaheri, M.; Khamseh, S.; Sari, M.G.; Zarrintaj, P.; Saeb, M.R.; Mozafari, M. Diamond-like Carbon Thin Films Prepared by Pulsed-DC PE-CVD for Biomedical Applications. Surf. Innov. 2018, 6, 167–175. [Google Scholar] [CrossRef]
- Wachesk, C.C.; Seabra, S.H.; dos Santos, T.A.T.; Trava-Airoldi, V.J.; Lobo, A.O.; Marciano, F.R. In Vivo Biocompatibility of Diamond-like Carbon Films Containing TiO2 Nanoparticles for Biomedical Applications. J. Mater. Sci. Mater. Med. 2021, 32. [Google Scholar] [CrossRef] [PubMed]
- Su, S.; Chen, W.; Zheng, M.; Lu, G.; Tang, W.; Huang, H.; Qu, D. Facile Fabrication of 3D-Printed Porous Ti6Al4V Scaffolds with a Sr-CaP Coating for Bone Regeneration. ACS Omega 2022, 7, 8391–8402. [Google Scholar] [CrossRef] [PubMed]
- Taranu, B.-O.; Ianasi, P.; Rus, S.F.; Bucur, A.I. Simultaneous Precipitation and Electrodeposition of Hydroxyapatite Coatings at Different Temperatures on Various Metal Substrates. Coatings 2022, 12, 288. [Google Scholar] [CrossRef]
- Feddes, B.; Vredenberg, A.M.; Wehner, M.; Wolke, J.C.G.; Jansen, J.A. Laser-Induced Crystallization of Calcium Phosphate Coatings on Polyethylene (PE). Biomaterials 2005, 26, 1645–1651. [Google Scholar] [CrossRef] [PubMed]
- Azem, F.A.; Delice, T.K.; Ungan, G.; Cakir, A. Investigation of Duty Cycle Effect on Corrosion Properties of Electrodeposited Calcium Phosphate Coatings. Mater. Sci. Eng. C 2016, 68, 681–686. [Google Scholar] [CrossRef] [PubMed]
- Heimann, R.B.; Lehmann, H.D. Deposition, Structure, Properties and Biological Function of Plasma-Sprayed Bioceramic Coatings. Bioceram. Coat. Med. Implant. 2015, 253–308. [Google Scholar] [CrossRef]
- Kaliaraj, G.S.; Siva, T.; Ramadoss, A. Surface Functionalized Bioceramics Coated on Metallic Implants for Biomedical and Anticorrosion Performance—A Review. J. Mater. Chem. B 2021, 9, 9433–9460. [Google Scholar] [CrossRef]
- Al-Amin, M.; Abdul Rani, A.M.; Abdu Aliyu, A.A.; Bryant, M.G.; Danish, M.; Ahmad, A. Bio-Ceramic Coatings Adhesion and Roughness of Biomaterials through PM-EDM: A Comprehensive Review. Mater. Manuf. Processes 2020, 35, 1157–1180. [Google Scholar] [CrossRef]
- Jeong, J.; Kim, J.H.; Shim, J.H.; Hwang, N.S.; Heo, C.Y. Bioactive Calcium Phosphate Materials and Applications in Bone Regeneration. Biomater. Res. 2019, 23, 1–11. [Google Scholar] [CrossRef]
- Sankar, M.; Suwas, S.; Balasubramanian, S.; Manivasagam, G. Comparison of Electrochemical Behavior of Hydroxyapatite Coated onto WE43 Mg Alloy by Electrophoretic and Pulsed Laser Deposition. Surf. Coat. Technol. 2017, 309, 840–848. [Google Scholar] [CrossRef]
- Yugeswaran, S.; Kobayashi, A.; Ucisik, A.H.; Subramanian, B. Characterization of Gas Tunnel Type Plasma Sprayed Hydroxyapatite–Nanostructure Titania Composite Coatings. Appl. Surf. Sci. 2015, 347, 48–56. [Google Scholar] [CrossRef]
- Trujillo, N.A.; Oldinski, R.A.; Ma, H.; Bryers, J.D.; Williams, J.D.; Popat, K.C. Antibacterial Effects of Silver-Doped Hydroxyapatite Thin Films Sputter Deposited on Titanium. Mater. Sci. Eng. C 2012, 32, 2135–2144. [Google Scholar] [CrossRef]
- Lett, J.A.; Sagadevan, S.; Paiman, S.; Mohammad, F.; Schirhagl, R.; Léonard, E.; Alshahateet, S.F.; Oh, W.C. Exploring the Thumbprints of Ag-Hydroxyapatite Composite as a Surface Coating Bone Material for the Implants. J. Mater. Res. Technol. 2020, 9, 12824–12833. [Google Scholar] [CrossRef]
- Predoi, D.; Iconaru, S.; Predoi, M.; Buton, N.; Motelica-Heino, M. Zinc Doped Hydroxyapatite Thin Films Prepared by Sol–Gel Spin Coating Procedure. Coatings 2019, 9, 156. [Google Scholar] [CrossRef]
- Wang, Q.; Li, P.; Tang, P.; Ge, X.; Ren, F.; Zhao, C.; Fang, J.; Wang, K.; Fang, L.; Li, Y.; et al. Experimental and Simulation Studies of Strontium/Fluoride-Codoped Hydroxyapatite Nanoparticles with Osteogenic and Antibacterial Activities. Colloids Surf. B Biointerfaces 2019, 182, 110359. [Google Scholar] [CrossRef]
- Sutha, S.; Dhineshbabu, N.R.; Prabhu, M.; Rajendran, V. Mg-Doped Hydroxyapatite/Chitosan Composite Coated 316L Stainless Steel Implants for Biomedical Applications. J. Nanosci. Nanotechnol. 2015, 15, 4178–4187. [Google Scholar] [CrossRef]
- Ofudje, E.A.; Adeogun, A.I.; Idowu, M.A.; Kareem, S.O. Synthesis and Characterization of Zn-Doped Hydroxyapatite: Scaffold Application, Antibacterial and Bioactivity Studies. Heliyon 2019, 5, e01716. [Google Scholar] [CrossRef]
- Chi, W.; Zou, J.; Ai, F.; Lin, Y.; Li, W.; Cao, C.; Yang, K.; Zhou, K. Research of Cu-Doped Hydroxyapatite Microbeads Fabricated by Pneumatic Extrusion Printing. Materials 2019, 12, 1769. [Google Scholar] [CrossRef]
- Prodan, A.M.; Iconaru, S.L.; Predoi, M.V.; Predoi, D.; Motelica-Heino, M.; Turculet, C.S.; Beuran, M. Silver-Doped Hydroxyapatite Thin Layers Obtained by Sol-Gel Spin Coating Procedure. Coatings 2019, 10, 14. [Google Scholar] [CrossRef]
- Mishra, V.K.; Bhattacharjee, B.N.; Parkash, O.; Kumar, D.; Rai, S.B. Mg-Doped Hydroxyapatite Nanoplates for Biomedical Applications: A Surfactant Assisted Microwave Synthesis and Spectroscopic Investigations. J. Alloys Compd. 2014, 614, 283–288. [Google Scholar] [CrossRef]
- Sun, T.W.; Zhu, Y.J. Solvothermal Growth of Ultralong Hydroxyapatite Nanowire Coating on Glass Substrate. Chem. Lett. 2019, 48, 1462–1464. [Google Scholar] [CrossRef]
- Predoi, D.; Iconaru, S.L.; Ciobanu, S.C.; Predoi, S.A.; Buton, N.; Megier, C.; Beuran, M. Development of Iron-Doped Hydroxyapatite Coatings. Coatings 2021, 11, 186. [Google Scholar] [CrossRef]
- Ciobanu, G.; Harja, M. Cerium-Doped Hydroxyapatite/Collagen Coatings on Titanium for Bone Implants. Ceram. Int. 2019, 45, 2852–2857. [Google Scholar] [CrossRef]
- Golovanova, O.A.; Zaits, A.V. Biomimetic Coating of a Titanium Substrate with Silicon-Substituted Hydroxyapatite. Inorg. Mater. 2018, 54, 1124–1130. [Google Scholar] [CrossRef]
- Zhang, L. Surface Modification of Titanium by Hydroxyapatite/CaSiO3/Chitosan Porous Bioceramic Coating. Int. J. Electrochem. Sci. 2020, 15. [Google Scholar] [CrossRef]
- Dhinasekaran, D.; Kaliaraj, G.S.; Jagannathan, M.; Rajendran, A.R.; Prakasarao, A.; Ganesan, S.; Subramanian, B. Pulsed Laser Deposition of Nanostructured Bioactive Glass and Hydroxyapatite Coatings: Microstructural and Electrochemical Characterization. Mater. Sci. Eng. C 2021, 130. [Google Scholar] [CrossRef] [PubMed]
- Zhang, L.; Pei, L.; Li, H.; Zhu, F. Design and Fabrication of Pyrolytic Carbon-SiC-Fluoridated Hydroxyapatite-Hydroxyapatite Multilayered Coating on Carbon Fibers. Appl. Surf. Sci. 2019, 473, 571–577. [Google Scholar] [CrossRef]
- Batebi, K.; Abbasi Khazaei, B.; Afshar, A. Characterization of Sol-Gel Derived Silver/Fluor-Hydroxyapatite Composite Coatings on Titanium Substrate. Surf. Coat. Technol. 2018, 352, 522–528. [Google Scholar] [CrossRef]
- Melero, H.C.; Sakai, R.T.; Vignatti, C.A.; Benedetti, A.V.; Fernández, J.; Guilemany, J.M.; Suegama, P.H. Corrosion Resistance Evaluation of HVOF Produced Hydroxyapatite and TiO2-Hydroxyapatite Coatings in Hanks’ Solution. Mater. Res. 2018, 21. [Google Scholar] [CrossRef]
- Evcin, A.; Buyukleblebici, B. Ti6A14V Coating with B2O3 and Al2O3 Containing Hydroxyapatite by HVOF Technique. Sci. Iran. 2019, 26, 1980–1989. [Google Scholar] [CrossRef]
- Farrokhi-Rad, M. Electrophoretic Deposition of Fiber Hydroxyapatite/Titania Nanocomposite Coatings. Ceram. Int. 2018, 44, 622–630. [Google Scholar] [CrossRef]
- Ionescu, R.N.; Totan, A.R.; Imre, M.M.; Țâncu, A.M.C.; Pantea, M.; Butucescu, M.; Farcașiu, A.T. Prosthetic Materials Used for Implant-Supported Restorations and Their Biochemical Oral Interactions: A Narrative Review. Materials 2022, 15, 1016. [Google Scholar] [CrossRef] [PubMed]
- Treccani, L.; Yvonne Klein, T.; Meder, F.; Pardun, K.; Rezwan, K. Functionalized Ceramics for Biomedical, Biotechnological and Environmental Applications. Acta Biomater. 2013, 9, 7115–7150. [Google Scholar] [CrossRef] [PubMed]
- Fu, L.; Khor, K.A.; Lim, J.P. Yttria Stabilized Zirconia Reinforced Hydroxyapatite Coatings. Surf. Coat. Technol. 2000, 127, 66–75. [Google Scholar] [CrossRef]
- Kaliaraj, G.S.; Muthaiah, B.; Alagarsamy, K.; Vishwakarma, V.; Kirubaharan, A.M.K. Role of Bovine Serum Albumin in the Degradation of Zirconia and Its Allotropes Coated 316L SS for Potential Bioimplants. Mater. Chem. Phys. 2021, 258, 123859. [Google Scholar] [CrossRef]
- Kaliaraj, G.S.; Vishwakarma, V.; Alagarsamy, K.; Kamalan Kirubaharan, A.M. Biological and Corrosion Behavior of M-ZrO2 and t-ZrO2 Coated 316L SS for Potential Biomedical Applications. Ceram. Int. 2018, 44, 14940–14946. [Google Scholar] [CrossRef]
- Pradhaban, G.; Kaliaraj, G.S.; Vishwakarma, V. Antibacterial Effects of Silver–Zirconia Composite Coatings Using Pulsed Laser Deposition onto 316L SS for Bio Implants. Prog. Biomater. 2014, 3, 123–130. [Google Scholar] [CrossRef]
- Santos, R.L.P.; Buciumeanu, M.; Silva, F.S.; Souza, J.C.M.; Nascimento, R.M.; Motta, F.V.; Henriques, B. Tribological Behavior of Zirconia-Reinforced Glass–Ceramic Composites in Artificial Saliva. Tribol. Int. 2016, 103, 379–387. [Google Scholar] [CrossRef]
- Berni, M.; Lopomo, N.; Marchiori, G.; Gambardella, A.; Boi, M.; Bianchi, M.; Visani, A.; Pavan, P.; Russo, A.; Marcacci, M. Tribological Characterization of Zirconia Coatings Deposited on Ti6Al4V Components for Orthopedic Applications. Mater. Sci. Eng. C 2016, 62, 643–655. [Google Scholar] [CrossRef]
- Kaliaraj, G.S.; Vishwakarma, V.; Kirubaharan, A.M.K. Biocompatible Zirconia-Coated 316 Stainless Steel with Anticorrosive Behavior for Biomedical Application. Ceram. Int. 2018, 44, 9780–9786. [Google Scholar] [CrossRef]
- Sergi, R.; Bellucci, D.; Cannillo, V. A Review of Bioactive Glass/Natural Polymer Composites: State of the Art. Materials 2020, 13, 5560. [Google Scholar] [CrossRef] [PubMed]
- Pachaiappan, R.; Rajendran, S.; Show, P.L.; Manavalan, K.; Naushad, M. Metal/Metal Oxide Nanocomposites for Bactericidal Effect: A Review. Chemosphere 2021, 272. [Google Scholar] [CrossRef] [PubMed]
- Crush, J.; Hussain, A.; Seah, K.T.M.; Khan, W.S. Bioactive Glass: Methods for Assessing Angiogenesis and Osteogenesis. Front. Cell Dev. Biol. 2021, 9. [Google Scholar] [CrossRef]
- Cannio, M.; Bellucci, D.; Roether, J.A.; Boccaccini, D.N.; Cannillo, V. Bioactive Glass Applications: A Literature Review of Human Clinical Trials. Materials 2021, 14, 5440. [Google Scholar] [CrossRef]
- Dey, P.; Pal, S.K.; Banerjee, I.; Sarkar, R. Effect of Addition of B2O3 to the Sol-Gel Synthesized 45S5 Bioglass. J. Aust. Ceram. Soc. 2020, 56, 1309–1322. [Google Scholar] [CrossRef]
- Henao, J.; Poblano-Salas, C.; Monsalve, M.; Corona-Castuera, J.; Barceinas-Sanchez, O. Bio-Active Glass Coatings Manufactured by Thermal Spray: A Status Report. J. Mater. Res. Technol. 2019, 8, 4965–4984. [Google Scholar] [CrossRef]
- Nawaz, Q.; Fastner, S.; Rehman, M.A.U.; Ferraris, S.; Perero, S.; di Confiengo, G.G.; Yavuz, E.; Ferraris, M.; Boccaccini, A.R. Multifunctional Stratified Composite Coatings by Electrophoretic Deposition and RF Co-Sputtering for Orthopaedic Implants. J. Mater. Sci. 2021, 56, 7920–7935. [Google Scholar] [CrossRef]
- Ashok raja, C.; Balakumar, S.; Durgalakshmi, D.; George, R.P.; Anandkumar, B.; Kamachi Mudali, U. Reduced Graphene Oxide/Nano-Bioglass Composites: Processing and Super-Anion Oxide Evaluation. RSC Adv. 2016, 6, 19657–19661. [Google Scholar] [CrossRef]
- Balakumar, S.; Bargavi, P.; Rajashree, P.; Anandkumar, B.; George, R.P. Decoration of 1-D Nano Bioactive Glass on Reduced Graphene Oxide Sheets: Strategies and in Vitro Bioactivity Studies. Mater. Sci. Eng. C 2018, 90, 85–94. [Google Scholar] [CrossRef]
- Ashok raja, C.; Balakumar, S.; Anandkumar, B.; George, R.P.; Kamachi Mudali, U. Formation of Bioactive Nano Hybrid Thin Films on Anodized Titanium via Electrophoretic Deposition Intended for Biomedical Applications. Mater. Today Commun. 2020, 25, 101666. [Google Scholar] [CrossRef]
- Chalisgaonkar, V.; Das, M.; Balla, V.K. Laser Processing of Ti Composite Coatings Reinforced with Hydroxyapatite and Bioglass. Addit. Manuf. 2018, 20, 134–143. [Google Scholar] [CrossRef]
- López-Cuevas, J.; Rendón-Angeles, J.C.; Méndez-Nonell, J.; Barrientos-Rodríguez, H. In Vitro Bioactivity of AISI 316L Stainless Steel Coated with Hydroxyapatite-Seeded 58S Bioglass. MRS Adv. 2019, 4, 3133–3142. [Google Scholar] [CrossRef]
- Estrada-Cabrera, E.; Torres-Ferrer, L.R.; Aztatzi-Aguilar, O.G.; de Vizcaya-Ruiz, A.; Meraz-Rios, M.A.; Zarate-Triviño, D.G.; Arizmendi-Morquecho, A.; de Luna Bugallo, A.; Prokhorov, E.; Luna-Barcenas, G. Chitosan-Bioglass Coatings on Partially Nanostructured Anodized Ti-6Al-4V Alloy for Biomedical Applications. Surf. Coat. Technol. 2019, 375, 468–476. [Google Scholar] [CrossRef]
- Nino, D.; Bayona, M.; Güiza, V.; Córdoba, E. Approach for Fabricating Bioglass Coatings on Reticulated Vitreous Carbon Foams for Tissue Engineering Applications. J. Phys. Conf. Ser. 2019, 1159, 012007. [Google Scholar] [CrossRef]
- Hosseini, S.; Farnoush, H. Characterization and in Vitro Bioactivity of Electrophoretically Deposited Mn-Modified Bioglass-Alginate Nanostructured Composite Coatings. Mater. Res. Express 2019, 6. [Google Scholar] [CrossRef]
- Singh, S.; Singh, G.; Bala, N. Analysis of in Vitro Corrosion Behavior and Hemocompatibility of Electrophoretically Deposited Bioglass-Chitosan-Iron Oxide Coating for Biomedical Applications. J. Mater. Res. 2020, 35, 1749–1761. [Google Scholar] [CrossRef]
- Say, Y.; Aksakal, B. Enhanced Corrosion Properties of Biological NiTi Alloy by Hydroxyapatite and Bioglass Based Biocomposite Coatings. J. Mater. Res. Technol. 2020, 9, 1712–1749. [Google Scholar] [CrossRef]
- Rojas, O.; Prudent, M.; López, M.E.; Vargas, F.; Ageorges, H. Influence of Atmospheric Plasma Spraying Parameters on Porosity Formation in Coatings Manufactured from 45S5 Bioglass® Powder. J. Therm. Spray Technol. 2020, 29, 185–198. [Google Scholar] [CrossRef]
- Li, X.; Zhitomirsky, I. Deposition of Poly(Methyl Methacrylate) and Composites Containing Bioceramics and Bioglass by Dip Coating Using Isopropanol-Water Co-Solvent. Prog. Org. Coat. 2020, 148. [Google Scholar] [CrossRef]
- Shafiee, B.M.; Torkaman, R.; Mahmoudi, M.; Emadi, R.; Derakhshan, M.; Karamian, E.; Tavangarian, F. Surface Modification of 316l Ss Implants by Applying Bioglass/Gelatin/Polycaprolactone Composite Coatings for Biomedical Applications. Coatings 2020, 10, 1220. [Google Scholar] [CrossRef]
- Haftbaradaran-Esfahani, M.; Ahmadian, M.; Nassajpour-Esfahani, A. Fabrication and Characterization of Porous Biomedical Vitallium Alloy with 58S Bioglass Coating Prepared by Sol-Gel Method. Appl. Surf. Sci. 2020, 506. [Google Scholar] [CrossRef]
- Azzouz, I.; Faure, J.; Khlifi, K.; Larbi, A.C.; Benhayoune, H. Electrophoretic Deposition of 45s5 Bioglass® Coatings on the Ti6al4v Prosthetic Alloy with Improved Mechanical Properties. Coatings 2020, 10, 1192. [Google Scholar] [CrossRef]
- Singh, S.; Singh, G.; Bala, N. Characterization, Electrochemical Behavior and in Vitro Hemocompatibility of Hydroxyapatite-Bioglass-Iron Oxide-Chitosan Composite Coating by Electrophoretic Deposition. Surf. Coat. Technol. 2021, 405. [Google Scholar] [CrossRef]

| Coatings | Applications | Advantages |
|---|---|---|
| Oxides (TiO2, ZrO2) | Oral implant application Maxillofacial reconstruction Ophthalmic implants | Good regenerative capability Corrosion resistance Antibacterial activities |
| Nitrides (TiN, ZrN, TiCN, ZrCN, TiAlN) and Oxynitrides (TiON, ZrON) | Dental implants Fracture fixation devices Components of joint endoprostheses | Resistance to corrosion Low frictional coefficient Better adhesion to the substrates |
| Carbon Based Coatings (a-C, DLC, NCD, carbides, and carbontirides) | Artificial heart valves Orthopedic fixation devices Sensors Artificial ligaments | Low frictional coefficient Excellent biocompatibility High blood compatibility Hydrophobicity |
| Calcium phosphates (CaP, HAp) and bioactive glass | Spinal implants Orthopedic implants Maxillofacial reconstruction Skull plates | High osteointegration capability Excellent biocompatibility Bioactivity |
| Materials | Advantages | Disadvantages | Applications |
|---|---|---|---|
| Polymers | Good performance in cyclic load applications, degrade completely over time. | Different cytotoxicity mechanism, inflammatory reactions, bone degradation, show higher corrosion rate. | Bearing surfaces [119] |
| Ceramics | Zero risk of transmitting diseases/immunogenicity, compression force resistance, corrosion resistance. | Low mechanical properties, high stress-shielding effects, lower rate of biodegradation, fracture toughness is poor. | Bearing surfaces |
| Stainless Steels | Better mechanical strength, high ductility, flexibility in bending, low manufacturing cost. | High stress-shielding effects, low resistance to corrosion, less osseointegration, biocompatibility issue. | Bone plates, pins, nails, screws, threads, steel threads, and sutures |
| Co-Cr based alloys | High strength, ductility, elastic modulus, stiffness, and density. | Higher modulus than bones, stress-shielding effects, not ideal for bearing surfaces in a joint, low frictional properties. | Orthopedic implants for knee, ankle, hip, shoulder, and fracture fixation devices |
| Titanium and its alloys | Good corrosion resistance, light weight, low density, good mechanical strength. | Poor tribological performance, high frictional coefficient, adhesive wear, and low abrasion resistance. | Total knee, hip replacement, bone plates, and screws for fixation and maxillofacial applications |
| Mg and its alloys | Low Young’s modulus, no stress shielding, biodegradable. | Biocompatibility issue, corrosion resistance, low mechanical integrity. | Mesh cage for segmental defects in bone, 3D scaffold design for better bone regeneration |
| S. No. | Coatings | Deposition Method | Significance | Ref. |
|---|---|---|---|---|
| 1 | PEEK coating on Ti alloy (Ti-13Nb-13Zr) | Electrophoretic deposition (EPD) | Excellent wear resistance Very good adhesion Low frictional coefficients | [136] |
| 2 | HAp/PEEK composite coating on PEEK substrate | Cold Spray coating | Better biocompatibility and osseointgration for clinical applications | [149] |
| 3 | SiC/PEEK composite coating on SS | electrostatic spray coating method | Scratch resistance Hardness increases | [150] |
| 4 | h-BN/bioactive glass/PEEK coating on SS 316L | Electrophoretic deposition (EPD) | Good adhesion strength Wetting behavior | [137] |
| 5 | PEEK/HAp on 316L SS | Electrophoretic deposition (EPD) | Good antibacterial activity | [151] |
| 6 | PEEK coating on Ti implant | Thermal spraying | Improved stability and fracture resistance Abrasion resistance | [152] |
| 7 | PEEK/ Bioglass composite coating on PEEK substrates | Cold gas spray | Better wear resistance Biomechanical performance | [143] |
| 8 | ZrO2/PEEK coating on Ti6Al4V substrates | Thermal spraying | Improved wettability Blood compatibility Great potential for medical applications | [153] |
| 9 | Al2O3/PEEK, SiO2/PEEK coatings on Ti6Al4V substrates | Thermal spraying | High hardness Optimum tribological properties Potential candidate for bearing material | [154] |
| S. No. | Coatings | Deposition Method | Significance | Refs. |
|---|---|---|---|---|
| 1 | Nano-TiN coating on Ti-6A1-4V | Magnetron sputtering | Enhanced hardness and anti-wear resistance, good hemocompatibility, and biocompatibility | [207] |
| 2 | TiN coating on Ti alloy | Cathodic arc deposition | Better corrosion protection Low wear rate Reduced coefficient of friction | [208,209] |
| 3 | TiON coating on 316L SS | Magnetron sputtering | Better adhesion Good resistance to corrosion | [210] |
| 4 | TiON coating on Ti substrates | Magnetron sputtering | Better biological activity Highly biocompatible | [211] |
| 5 | TiCN coating on Ni-Cr alloy | Magnetron sputtering | Good adhesion of fibroblasts Less cytotoxic | [212] |
| 6 | TiZr/a-C coatings on Ti substrate | Cathodic arc deposition | Good compatibility with human skin fibroblast cells Good human skin fibroblast cell viability | [213] |
| 7 | TiZrCN, TiNbCN, and TiSiCN coatings on steel substrates | Cathodic arc deposition | Better adhesion to the substrate Corrosion resistance | [214] |
| 8 | TiAlN coating | Multi arc ion plating technique | Better tribological performance | [215] |
| 9 | Nanolayer CrAlN/TiSiN coating on steel substrates | Magnetron sputtering | Excellent tribological performance | [216] |
| 10 | TiCN/TiAlN and TiAlN/TiCN bilayer nitride coatings on cemented carbide substrates | Cathodic arc deposition | Higher hardness High scratch resistance | [217] |
| 11 | CoCrMoC/CrN and CrN/CoCrMoC coatings on medical grade SS substrates | Magnetron sputtering | Better tribo-corrosion behavior | [218] |
| S. No. | Coatings | Deposition Method | Significance | Ref. |
|---|---|---|---|---|
| 1 | DLC on Ti alloy | Plasma immersion ion deposition (PIID) | Improvement in tribo-corrosion behavior | [240] |
| 2 | Si-DLC on Polyethylene (PE) substrates | Plasma and laser-based processing methods | Improvement in hydrophobicity, lubricity, and electrical conductivity | [241] |
| 3 | Carbon coatings on X39CR13 and 316LVM steels | Magnetron sputtering | Improved adhesion and wettability properties | [242] |
| 4 | Amorphous carbon/diamond-like carbon (a-C:H) coatings on PEEK substrate | Plasma enhanced chemical vapor deposition | No toxicity issues and better biological performance | [243] |
| 5 | DLC with Zr interlayers on Ti alloy | Magnetron sputtering | Reduced coefficient of friction | [244] |
| 6 | Si-DLC Coatings on Ti alloy | Magnetron sputtering | High level of biocompatibility due to the presence of Si | [245] |
| 7 | a-C:H coating on Co-Cr alloy | PVD/PE-CVD | Excellent mechanical properties, high hardness, and elastic modulus | [246] |
| 8 | Si doped DLC on Ti alloy | Magnetron sputtering | Reduced microbial colonization of E. coli | [247] |
| 9 | DLC on stainless steel | Pulsed DC PE-CVD | Improved biocompatibility and corrosion resistance | [248] |
| 10 | DLC with TiO2 on stainless steel | PE-CVD | Better biocompatibility and antimicrobial activity | [249] |
| S. No. | Coatings | Deposition Method | Significance | Ref. |
|---|---|---|---|---|
| HAp nanowire coating on glass substrate | Solvothermal method | Excellent apatite-forming ability | [269] | |
| Fe doped HAp on Si substrate | Co-precipitation method | Promote better proliferation and adhesion of the osteoblast cells | [270] | |
| Ce doped HAp/collagen coating on Ti surface | Biomimetic method | Better antibacterial efficacy against Escherichia coli and Staphylococcus aureus bacteria than HAp coating | [271] | |
| Si substituted HAp coating on Ti substrate | Precipitation method | Favorable regeneration of crystalline Si-HA layer | [272] | |
| HAp/CaSiO3/Chitosan Porous coating on Ti substrate | EPD | Improved bioactivity and biocompatibility | [273] | |
| Bioactive glass/HAp coatings on Ti substrate | Pulsed laser deposition | Significant bioactivity, cytocompatibility, and hemocompatibility | [274] | |
| PyC/SiC/HAp coating on carbon fibers | Chemical vapor deposition/pulsed electrochemical deposition | Excellent corrosion resistance, induces the nucleation process and growth of bone-like apatite | [275] | |
| PEEK/HAp composite coating on 316L SS substrate | Electrophoretic deposition | Enhanced in vitro bioactivity | [148] | |
| Ag/HAp coating on Ti substrate | Sol-gel route | Enhanced antibacterial activity and better corrosion protection | [276] | |
| TiO2/HAp coating on Ti substrate | High velocity oxy fuel (HVOF) method | Improved corrosion resistance | [277] | |
| B2O3/Al2O3/HAp coating on Ti substrate | High velocity oxy fuel (HVOF) method | Improved adhesion strength | [278] | |
| TiO2/HAp nanocomposite coating on 316L SS substrate | Electrophoretic deposition | Excellent corrosion protection under SBF medium | [279] |
| S. No. | Coatings | Substrate | Deposition Method | Significance | Ref. |
|---|---|---|---|---|---|
| 1 | Titanium, HAp, Bioactive glass wt.% (57–60 SiO2, 21–24 CaO, 9–11 Na2O, 2–3P2O5, 0.5–1.5 TiO2, and 2–3B2O3) | Ti-alloy—Ti6Al4 V | Laser engineered net shaping | Improved hardness and wear resistance | [299] |
| 2 | 58S Bioactive glass (molar composition of 35% CaO, 60% SiO2, and 5% P2O5) seeded in HAp | Commercial AISI 316L SS | Cold uniaxial pressing | Seeding of HAp increased the hardness as well as apatite layer formation | [300] |
| 3 | Bioglass with silver nanoparticles and Chitosan | Ti-alloy—Ti6Al4 V | Electrophoretic deposition | Increased coating uniformity and nanoscale roughness for bioactivity | [301] |
| 4 | (1) 65% SiO2, 5% P2O5, and 30% CaO, (2) 45% SiO2, 5% P2O5, and 50% CaO | Carbon foam | Dip Coating | Compact and dense coating is reported in 65% rather than 45% SiO2 | [302] |
| 5 | Manganese modified Bioglass/alginate | 316L SS | Electrophoretic deposition | Increase in manganese improves the corrosion resistance in SBF | [303] |
| 6 | Bioglass composite with chitosan and iron oxide nanoparticles | Ti-alloy—Ti–13Nb–13Zr | Electrophoretic deposition | Better corrosion resistance, coating adhesion, and hydrophilicity | [304] |
| 7 | Silver incorporated HAp and Bioglass | Nickel titanium alloy | Dip coating | Increased corrosion resistance and coating adhesion | [305] |
| 8 | Bioglass | AISI 304L SS | APS | Improved mechanical strength and corrosion resistance | [306] |
| 9 | Bioglass, TiO2, Al2O3, and Hap composite with PMMA | Stainless steel 304 | Dip coating | PMMA-TiO2 coating exhibited higher corrosion resistance than other composites coatings | [307] |
| 10 | 58S bioactive glass-gelatin-polycaprolactone composite | 316L SS | Electrospinning | Increase in bioactive glass weight % improved surface Roughness and adhesion strength, exhibited good corrosion resistance, apatite formation and cell viability | [308] |
| 11 | 58S Bioactive glass | Vitallium alloy | Dip coating | Decreased porosity and increased bioactivity | [309] |
| 12 | Bioglass | Ti6Al4V alloy | Electrophoretic deposition | Scratch resistance, hardness, and coating bonding strength | [310] |
| 13 | HAp-Bioglass-Iron oxide composite | Ti-alloy—Ti-13Nb-13Zr | Electrophoretic deposition | Corrosion resistance and non-toxic effects | [311] |
| 14 | Reduced graphene oxide—Bioglass sol-gel composite | Grade 2 titanium | Electrophoretic deposition | rGO facilitated low hemolysis and improved cell proliferation | [298] |
Publisher’s Note: MDPI stays neutral with regard to jurisdictional claims in published maps and institutional affiliations. |
© 2022 by the authors. Licensee MDPI, Basel, Switzerland. This article is an open access article distributed under the terms and conditions of the Creative Commons Attribution (CC BY) license (https://creativecommons.org/licenses/by/4.0/).
Share and Cite
Amirtharaj Mosas, K.K.; Chandrasekar, A.R.; Dasan, A.; Pakseresht, A.; Galusek, D. Recent Advancements in Materials and Coatings for Biomedical Implants. Gels 2022, 8, 323. https://doi.org/10.3390/gels8050323
Amirtharaj Mosas KK, Chandrasekar AR, Dasan A, Pakseresht A, Galusek D. Recent Advancements in Materials and Coatings for Biomedical Implants. Gels. 2022; 8(5):323. https://doi.org/10.3390/gels8050323
Chicago/Turabian StyleAmirtharaj Mosas, Kamalan Kirubaharan, Ashok Raja Chandrasekar, Arish Dasan, Amirhossein Pakseresht, and Dušan Galusek. 2022. "Recent Advancements in Materials and Coatings for Biomedical Implants" Gels 8, no. 5: 323. https://doi.org/10.3390/gels8050323
APA StyleAmirtharaj Mosas, K. K., Chandrasekar, A. R., Dasan, A., Pakseresht, A., & Galusek, D. (2022). Recent Advancements in Materials and Coatings for Biomedical Implants. Gels, 8(5), 323. https://doi.org/10.3390/gels8050323

